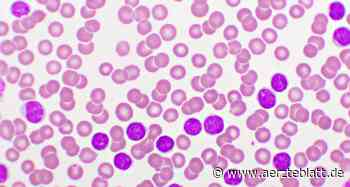
Blinatumomab verbessert Ergebnisse der Chemotherapie bei B-Zell-ALL im Kindesalter

✗ Close categories
 Aktuelle Nachrichten
Aktuelle Nachrichten
 Allgemeine Google News
Allgemeine Google News
 Apps & Smartphone
Apps & Smartphone
 Ausland
Ausland
 Auto
Auto
 Bildung & Ausbildung
Bildung & Ausbildung
 Christliche Glaube
Christliche Glaube
 Club & Modezeitschrift
Club & Modezeitschrift
 Coronavirus
Coronavirus
 Digital
Digital
 Ebola
Ebola
 Erotik
Erotik
 Erziehung & Kind
Erziehung & Kind
 False
False
 Film
Film
 Food & Rezepte
Food & Rezepte
 Frau
Frau
 Freizeitparks
Freizeitparks
 Gadgets
Gadgets
 Gesundheit
Gesundheit
 Haus & Garten
Haus & Garten
 Internet
Internet
 Job & karriere
Job & karriere
 Kabarett
Kabarett
 Kinderbetreuung
Kinderbetreuung
 Konsument
Konsument
 kulinarisch
kulinarisch
 Kultur & Medien
Kultur & Medien
 Kunst & Kutlur
Kunst & Kutlur
 Lifestyle
Lifestyle
 Literatur
Literatur
 Lustige Videos
Lustige Videos
 Medien
Medien
 medizinisch
medizinisch
 Mode
Mode
 Musik
Musik
 Nachrichten-Videos
Nachrichten-Videos
 Nachtleben
Nachtleben
 Natur & Umwelt
Natur & Umwelt
 Olympia
Olympia
 Online Gambling
Online Gambling
 Online Trends
Online Trends
 Partnerschaft
Partnerschaft
 Politik Ausland
Politik Ausland
 Politik Inland
Politik Inland
 Psychologie
Psychologie
 Raumfahrt
Raumfahrt
 Reise
Reise
 Royals
Royals
 Sex & Beziehungen
Sex & Beziehungen
 Social Media
Social Media
 Spiele
Spiele
 Sport
Sport
 Sucht
Sucht
 Technologie
Technologie
 Tieren
Tieren
 TV & Kino
TV & Kino
 UFO
UFO
 Unterhaltung
Unterhaltung
 Verbrechen
Verbrechen
 Verschwörungstheorien und alternative
Verschwörungstheorien und alternative
 Versicherungen
Versicherungen
 Video-Blog
Video-Blog
 Weblogs
Weblogs
 Weine
Weine
 Wellness
Wellness
 Wetter & Verkehr
Wetter & Verkehr
 Wirtschaft
Wirtschaft
 Wissenschaft
Wissenschaft
✗ Close categories
✗ Close categories
✗ Close categories
 1. FC Köln
1. FC Köln
 American football
American football
 Badminton
Badminton
 Baseball
Baseball
 Basketball
Basketball
 Bayer 04 Leverkusen
Bayer 04 Leverkusen
 Behindertensport
Behindertensport
 Billard
Billard
 Bodybuilding
Bodybuilding
 Bogenschiesse
Bogenschiesse
 Borussia Dortmund
Borussia Dortmund
 Borussia Mönchengladbach
Borussia Mönchengladbach
 Bowling
Bowling
 Boxen
Boxen
 Bundesliga
Bundesliga
 Champions League
Champions League
 Curling
Curling
 Darts
Darts
 Deutsches Sportabzeichen
Deutsches Sportabzeichen
 Die Mannschaft
Die Mannschaft
 Eintracht Frankfurt
Eintracht Frankfurt
 Eishockey
Eishockey
 FC Augsburg
FC Augsburg
 FC Bayern München
FC Bayern München
 Floorball
Floorball
 Formel 1
Formel 1
 Formel 1 - Force India Videos
Formel 1 - Force India Videos
 Formel 1 - Infiniti Red Bull Racing Videos
Formel 1 - Infiniti Red Bull Racing Videos
 Formel 1 - Live-stream und Nachrichten
Formel 1 - Live-stream und Nachrichten
 Formel 1 - McLaren Videos
Formel 1 - McLaren Videos
 Formel 1 - Mercedes AMG Petronas Videos
Formel 1 - Mercedes AMG Petronas Videos
 Formel 1 - Sauber F1 Team Videos
Formel 1 - Sauber F1 Team Videos
 Formel 1 - Scuderia Ferrari Videos
Formel 1 - Scuderia Ferrari Videos
 Formel 1 - Scuderia Toro Rosso Videos
Formel 1 - Scuderia Toro Rosso Videos
 Formel 1 - Team Lotus Videos
Formel 1 - Team Lotus Videos
 Formel 1 - Williams Martini videos
Formel 1 - Williams Martini videos
 FSV Mainz 05
FSV Mainz 05
 Fußball
Fußball
 Gleitschirmfliegen
Gleitschirmfliegen
 Golf
Golf
 Hamburger SV
Hamburger SV
 Handball
Handball
 Hannover 96
Hannover 96
 Hertha BSC
Hertha BSC
 Hockey
Hockey
 Ju-Jutsu
Ju-Jutsu
 Judo
Judo
 Kanu
Kanu
 Kanu-Polo
Kanu-Polo
 Karate
Karate
 Kite-Surfen
Kite-Surfen
 Kleinfeld-Fussbal
Kleinfeld-Fussbal
 Korfball
Korfball
 Kraftdreikampf
Kraftdreikampf
 Kunstradsport
Kunstradsport
 Laufen
Laufen
 Leichtathletik
Leichtathletik
 Motocross
Motocross
 Motorsport
Motorsport
 Mountainbike
Mountainbike
 Pferdesport
Pferdesport
 Radsport
Radsport
 Rettungsschwimmen
Rettungsschwimmen
 Rhythmische Sportgymnastik
Rhythmische Sportgymnastik
 Rudern
Rudern
 Rugby
Rugby
 SC Freiburg
SC Freiburg
 SC Paderborn 07
SC Paderborn 07
 Schalke 04
Schalke 04
 Schwimmen
Schwimmen
 Segeln
Segeln
 Skateboard
Skateboard
 Sledge-Eishockey
Sledge-Eishockey
 Snowboard
Snowboard
 Softball
Softball
 Sonstiges
Sonstiges
 Spartan Race
Spartan Race
 Sportaerobic
Sportaerobic
 Sportklettern
Sportklettern
 Squash
Squash
 Sumo
Sumo
 SV Werder
SV Werder
 Taekwondo
Taekwondo
 Tanzen
Tanzen
 Tauziehen
Tauziehen
 Tennis
Tennis
 Tischtennis
Tischtennis
 Triathlon
Triathlon
 TSG 1899 Hoffenheim
TSG 1899 Hoffenheim
 TURNEN
TURNEN
 VfL Wolfsburg
VfL Wolfsburg
 Volleyball
Volleyball
 Wakeboard
Wakeboard
 Wasserball
Wasserball
 Wasserski
Wasserski
✗ Close categories
✗ Close categories
✗ Close categories
 Aachen
Aachen
 Aalen
Aalen
 Abensberg
Abensberg
 Achern
Achern
 Achim
Achim
 Adorf/Vogtl.
Adorf/Vogtl.
 Aerzen
Aerzen
 Affalterbach
Affalterbach
 Affing
Affing
 Ahaus
Ahaus
 Ahlen
Ahlen
 Ahrensburg
Ahrensburg
 Ahrensfelde
Ahrensfelde
 Aichach
Aichach
 Aichtal
Aichtal
 Aidlingen
Aidlingen
 Aitrach
Aitrach
 Albbruck
Albbruck
 Albstadt
Albstadt
 Aldenhoven
Aldenhoven
 Aldingen
Aldingen
 Alfdorf
Alfdorf
 Alfeld
Alfeld
 Alfter
Alfter
 Algermissen
Algermissen
 Allendorf
Allendorf
 Allershausen
Allershausen
 Alpen
Alpen
 Alsbach-Hahnlein
Alsbach-Hahnlein
 Alsdorf
Alsdorf
 Alsfeld
Alsfeld
 Altdorf bei Nurnberg
Altdorf bei Nurnberg
 Alteglofsheim
Alteglofsheim
 Altena
Altena
 Altenberge
Altenberge
 Altenburg
Altenburg
 Altenholz
Altenholz
 Altenkirchen
Altenkirchen
 Altenmarkt an der Alz
Altenmarkt an der Alz
 Altenstadt
Altenstadt
 Altensteig
Altensteig
 Altentreptow
Altentreptow
 Althegnenberg
Althegnenberg
 Altleiningen
Altleiningen
 Altmannstein
Altmannstein
 Altomunster
Altomunster
 Altotting
Altotting
 Alzenau
Alzenau
 Alzey
Alzey
 Amberg
Amberg
 Ampfing
Ampfing
 Andernach
Andernach
 Anklam
Anklam
 Annaberg-Buchholz
Annaberg-Buchholz
 Annweiler
Annweiler
 Anrochte
Anrochte
 Ansbach
Ansbach
 Apen
Apen
 Apfelstadt
Apfelstadt
 Apolda
Apolda
 Aresing
Aresing
 Armsheim
Armsheim
 Arnsberg
Arnsberg
 Arnstadt
Arnstadt
 Arnstorf
Arnstorf
 Arolsen
Arolsen
 Asbach
Asbach
 Aschaffenburg
Aschaffenburg
 Ascheberg
Ascheberg
 Aschersleben
Aschersleben
 Aschheim
Aschheim
 Asperg
Asperg
 Asslar
Asslar
 Attendorn
Attendorn
 Attenhofen
Attenhofen
 Aue
Aue
 Auerbach
Auerbach
 Augsburg
Augsburg
 Aurich
Aurich
 Babenhausen, Bavaria
Babenhausen, Bavaria
 Babenhausen, Hessen
Babenhausen, Hessen
 Backnang
Backnang
 Bad Aibling
Bad Aibling
 Bad Belzig
Bad Belzig
 Bad Bentheim
Bad Bentheim
 Bad Berka
Bad Berka
 Bad Berleburg
Bad Berleburg
 Bad Berneck
Bad Berneck
 Bad Bramstedt
Bad Bramstedt
 Bad Breisig
Bad Breisig
 Bad Camberg
Bad Camberg
 Bad Doberan
Bad Doberan
 Bad Driburg
Bad Driburg
 Bad Duben
Bad Duben
 Bad Durkheim
Bad Durkheim
 Bad Durrheim
Bad Durrheim
 Bad Ems
Bad Ems
 Bad Essen
Bad Essen
 Bad Fallingbostel
Bad Fallingbostel
 Bad Feilnbach
Bad Feilnbach
 Bad Friedrichshall
Bad Friedrichshall
 Bad Gandersheim
Bad Gandersheim
 Bad Griesbach
Bad Griesbach
 Bad Harzburg
Bad Harzburg
 Bad Hersfeld
Bad Hersfeld
 Bad Hindelang
Bad Hindelang
 Bad Homburg
Bad Homburg
 Bad Honnef
Bad Honnef
 Bad Kissingen
Bad Kissingen
 Bad Kreuznach
Bad Kreuznach
 Bad Krozingen
Bad Krozingen
 Bad Laer
Bad Laer
 Bad Langensalza
Bad Langensalza
 Bad Liebenwerda
Bad Liebenwerda
 Bad Liebenzell
Bad Liebenzell
 Bad Marienberg
Bad Marienberg
 Bad Mergentheim
Bad Mergentheim
 Bad Munder
Bad Munder
 Bad Munstereifel
Bad Munstereifel
 Bad Nauheim
Bad Nauheim
 Bad Neuenahr-Ahrweiler
Bad Neuenahr-Ahrweiler
 Bad Neustadt an der Saale
Bad Neustadt an der Saale
 Bad Oeynhausen
Bad Oeynhausen
 Bad Oldesloe
Bad Oldesloe
 Bad Rappenau
Bad Rappenau
 Bad Reichenhall
Bad Reichenhall
 Bad Rothenfelde
Bad Rothenfelde
 Bad Saarow
Bad Saarow
 Bad Sackingen
Bad Sackingen
 Bad Salzuflen
Bad Salzuflen
 Bad Salzungen
Bad Salzungen
 Bad Sassendorf
Bad Sassendorf
 Bad Schonborn
Bad Schonborn
 Bad Schwalbach
Bad Schwalbach
 Bad Schwartau
Bad Schwartau
 Bad Segeberg
Bad Segeberg
 Bad Soden
Bad Soden
 Bad Soden-Salmunster
Bad Soden-Salmunster
 Bad Sooden-Allendorf
Bad Sooden-Allendorf
 Bad Tolz
Bad Tolz
 Bad Urach
Bad Urach
 Bad Vilbel
Bad Vilbel
 Bad Waldsee
Bad Waldsee
 Bad Wildbad
Bad Wildbad
 Bad Wildungen
Bad Wildungen
 Bad Windsheim
Bad Windsheim
 Bad Worishofen
Bad Worishofen
 Bad Wunnenberg
Bad Wunnenberg
 Bad Wurzach
Bad Wurzach
 Bad Zwischenahn
Bad Zwischenahn
 Baden-Baden
Baden-Baden
 Baden-Württemberg
Baden-Württemberg
 Baesweiler
Baesweiler
 Baierbrunn
Baierbrunn
 Baiersbronn
Baiersbronn
 Balingen
Balingen
 Balve
Balve
 Bamberg
Bamberg
 Bargteheide
Bargteheide
 Barleben
Barleben
 Barmstedt
Barmstedt
 Barnstorf
Barnstorf
 Barsbuttel
Barsbuttel
 Barsinghausen
Barsinghausen
 Barssel
Barssel
 Bassum
Bassum
 Baumholder
Baumholder
 Baunatal
Baunatal
 Bautzen
Bautzen
 Bayern
Bayern
 Bayreuth
Bayreuth
 Bebra
Bebra
 Beckum
Beckum
 Bedburg
Bedburg
 Beelitz
Beelitz
 Beeskow
Beeskow
 Bellenberg
Bellenberg
 Bellheim
Bellheim
 Bendorf
Bendorf
 Bensheim
Bensheim
 Berching
Berching
 Berchtesgaden
Berchtesgaden
 Berg
Berg
 Bergen
Bergen
 Bergen auf Rugen
Bergen auf Rugen
 Bergheim
Bergheim
 Bergisch Gladbach
Bergisch Gladbach
 Bergkamen
Bergkamen
 Bergtheim
Bergtheim
 Berka
Berka
 Berlin
Berlin
 Bernau bei Berlin
Bernau bei Berlin
 Bernburg
Bernburg
 Bernkastel-Kues
Bernkastel-Kues
 Bernstadt auf dem Eigen
Bernstadt auf dem Eigen
 Bersenbruck
Bersenbruck
 Besigheim
Besigheim
 Bessenbach
Bessenbach
 Bestwig
Bestwig
 Betzdorf
Betzdorf
 Betzigau
Betzigau
 Beverstedt
Beverstedt
 Bexbach
Bexbach
 Biberach
Biberach
 Biblis
Biblis
 Biedenkopf
Biedenkopf
 Bielefeld
Bielefeld
 Bietigheim
Bietigheim
 Bietigheim-Bissingen
Bietigheim-Bissingen
 Billerbeck
Billerbeck
 Bingen
Bingen
 Binz
Binz
 Birkenau
Birkenau
 Birkenfeld, Baden-Württemberg
Birkenfeld, Baden-Württemberg
 Birkenfeld, Rijnland-Palts
Birkenfeld, Rijnland-Palts
 Birkenwerder
Birkenwerder
 Bischofsheim
Bischofsheim
 Bischofswerda
Bischofswerda
 Bissendorf
Bissendorf
 Bissingen
Bissingen
 Bitburg
Bitburg
 Bitterfeld-Wolfen
Bitterfeld-Wolfen
 Blankenburg
Blankenburg
 Blankenfelde-Mahlow
Blankenfelde-Mahlow
 Blaubeuren
Blaubeuren
 Blieskastel
Blieskastel
 Blomberg
Blomberg
 Blumberg
Blumberg
 Bobingen
Bobingen
 Boblingen
Boblingen
 Bocholt
Bocholt
 Bochum
Bochum
 Bockenem
Bockenem
 Bodenheim
Bodenheim
 Bodenwohr
Bodenwohr
 Bodman-Ludwigshafen
Bodman-Ludwigshafen
 Bohmte
Bohmte
 Boizenburg
Boizenburg
 Boll
Boll
 Bollendorf
Bollendorf
 Bonen
Bonen
 Bonn
Bonn
 Bonndorf
Bonndorf
 Bonnigheim
Bonnigheim
 Boos
Boos
 Bopfingen
Bopfingen
 Boppard
Boppard
 Borchen
Borchen
 Bordesholm
Bordesholm
 Borgholzhausen
Borgholzhausen
 Borken
Borken
 Borna
Borna
 Bornheim, Rheinland
Bornheim, Rheinland
 Bottendorf
Bottendorf
 Bottrop
Bottrop
 Botzingen
Botzingen
 Bovenden
Bovenden
 Brackenheim
Brackenheim
 Brake
Brake
 Brakel
Brakel
 Bramsche
Bramsche
 Brandenburg
Brandenburg
 Brandis
Brandis
 Braunfels
Braunfels
 Braunlingen
Braunlingen
 Braunschweig
Braunschweig
 Brechen
Brechen
 Breisach
Breisach
 Breitenfelde
Breitenfelde
 Bremen
Bremen
 Bremerhaven
Bremerhaven
 Bremervorde
Bremervorde
 Bretten
Bretten
 Bretzfeld
Bretzfeld
 Brilon
Brilon
 Bruchkobel
Bruchkobel
 Bruchmuhlbach-Miesau
Bruchmuhlbach-Miesau
 Bruchsal
Bruchsal
 Bruck in der Oberpfalz
Bruck in der Oberpfalz
 Bruckmuhl
Bruckmuhl
 Bruel
Bruel
 Bruggen
Bruggen
 Bruhl, Baden-Wurttemberg
Bruhl, Baden-Wurttemberg
 Bruhl, North Rhine-Westphalia
Bruhl, North Rhine-Westphalia
 Brunsbuttel
Brunsbuttel
 Brunswick
Brunswick
 Buch am Erlbach
Buch am Erlbach
 Buchen
Buchen
 Buchholz in der Nordheide
Buchholz in der Nordheide
 Buchloe
Buchloe
 Buckeburg
Buckeburg
 Budelsdorf
Budelsdorf
 Budingen
Budingen
 Buhl
Buhl
 Bunde
Bunde
 Burbach
Burbach
 Buren
Buren
 Burg bei Magdeburg
Burg bei Magdeburg
 Burgau
Burgau
 Burgdorf
Burgdorf
 Burgebrach
Burgebrach
 Burghaslach
Burghaslach
 Burghausen
Burghausen
 Burgkirchen an der Alz
Burgkirchen an der Alz
 Burgkunstadt
Burgkunstadt
 Burglengenfeld
Burglengenfeld
 Burgsalach
Burgsalach
 Burgstadt
Burgstadt
 Burgthann
Burgthann
 Burgwedel
Burgwedel
 Burladingen
Burladingen
 Burscheid
Burscheid
 Burstadt
Burstadt
 Buseck
Buseck
 Buttelborn
Buttelborn
 Butzbach
Butzbach
 Buxtehude
Buxtehude
 Cadolzburg
Cadolzburg
 Calw
Calw
 Castrop-Rauxel
Castrop-Rauxel
 Celle
Celle
 Cham
Cham
 Chemnitz
Chemnitz
 Clausthal-Zellerfeld
Clausthal-Zellerfeld
 Cloppenburg
Cloppenburg
 Coburg
Coburg
 Cochem
Cochem
 Coesfeld
Coesfeld
 Cologne
Cologne
 Coswig
Coswig
 Cottbus
Cottbus
 Crailsheim
Crailsheim
 Crawinkel
Crawinkel
 Cremlingen
Cremlingen
 Crimmitschau
Crimmitschau
 Cuxhaven
Cuxhaven
 Dachau
Dachau
 Dahlewitz
Dahlewitz
 Dallgow-Doberitz
Dallgow-Doberitz
 Damme
Damme
 Dannenberg
Dannenberg
 Dannstadt-Schauernheim
Dannstadt-Schauernheim
 Darmstadt
Darmstadt
 Dassel
Dassel
 Datteln
Datteln
 Daun
Daun
 Dautphetal
Dautphetal
 Deggendorf
Deggendorf
 Deidesheim
Deidesheim
 Deisslingen
Deisslingen
 Deizisau
Deizisau
 Delbruck
Delbruck
 Delitzsch
Delitzsch
 Delmenhorst
Delmenhorst
 Denkendorf
Denkendorf
 Dessau-Rosslau
Dessau-Rosslau
 Detmold
Detmold
 Dettelbach
Dettelbach
 Dettenheim
Dettenheim
 Dettingen
Dettingen
 Dettingen an der Erms
Dettingen an der Erms
 Dieburg
Dieburg
 Diepholz
Diepholz
 Diessen
Diessen
 Dietersdorf
Dietersdorf
 Dietfurt
Dietfurt
 Dietzenbach
Dietzenbach
 Diez
Diez
 Dillenburg
Dillenburg
 Dillingen an der Donau
Dillingen an der Donau
 Dillingen, Saarland
Dillingen, Saarland
 Dingolfing
Dingolfing
 Dinkelsbuhl
Dinkelsbuhl
 Dinklage
Dinklage
 Dinslaken
Dinslaken
 Dissen
Dissen
 Ditzingen
Ditzingen
 Dobeln
Dobeln
 Dohna
Dohna
 Dolgesheim
Dolgesheim
 Dombuhl
Dombuhl
 Donaueschingen
Donaueschingen
 Donauworth
Donauworth
 Donzdorf
Donzdorf
 Dorfen
Dorfen
 Dormagen
Dormagen
 Dornach
Dornach
 Dornburg
Dornburg
 Dornstadt
Dornstadt
 Dorpen
Dorpen
 Dorsten
Dorsten
 Dortmund
Dortmund
 Dotternhausen
Dotternhausen
 Dransfeld
Dransfeld
 Dreieich
Dreieich
 Drensteinfurt
Drensteinfurt
 Dresden
Dresden
 Drochtersen
Drochtersen
 Drolshagen
Drolshagen
 Duderstadt
Duderstadt
 Duisburg
Duisburg
 Dulmen
Dulmen
 Duren
Duren
 Dusseldorf
Dusseldorf
 Dusslingen
Dusslingen
 Eberbach
Eberbach
 Ebern
Ebern
 Ebersbach an der Fils
Ebersbach an der Fils
 Ebersberg
Ebersberg
 Ebersdorf
Ebersdorf
 Eberswalde
Eberswalde
 Eching
Eching
 Eckernforde
Eckernforde
 Edelsfeld
Edelsfeld
 Edenkoben
Edenkoben
 Ederheim
Ederheim
 Edewecht
Edewecht
 Egelsbach
Egelsbach
 Egenhofen
Egenhofen
 Eggenfelden
Eggenfelden
 Eggenstein-Leopoldshafen
Eggenstein-Leopoldshafen
 Eggolsheim
Eggolsheim
 Ehingen
Ehingen
 Ehningen
Ehningen
 Ehrenkirchen
Ehrenkirchen
 Eibelstadt
Eibelstadt
 Eichenzell
Eichenzell
 Eichstatt
Eichstatt
 Eilenburg
Eilenburg
 Einbeck
Einbeck
 Einsiedlerhof
Einsiedlerhof
 Eisenach
Eisenach
 Eisenberg, Pfalz
Eisenberg, Pfalz
 Eisenberg, Thüringen
Eisenberg, Thüringen
 Eisenhuttenstadt
Eisenhuttenstadt
 Eisleben
Eisleben
 Eislingen
Eislingen
 Eitorf
Eitorf
 Ellwangen
Ellwangen
 Elm
Elm
 Elmshorn
Elmshorn
 Elsdorf
Elsdorf
 Elsenfeld
Elsenfeld
 Elsfleth
Elsfleth
 Elsterwerda
Elsterwerda
 Eltville
Eltville
 Elz
Elz
 Emden
Emden
 Emlichheim
Emlichheim
 Emmendingen
Emmendingen
 Emmerich
Emmerich
 Empfingen
Empfingen
 Emsdetten
Emsdetten
 Emstek
Emstek
 Engelskirchen
Engelskirchen
 Engen
Engen
 Enger
Enger
 Eningen
Eningen
 Ennepetal
Ennepetal
 Ennigerloh
Ennigerloh
 Ense
Ense
 Eppelborn
Eppelborn
 Eppelheim
Eppelheim
 Eppingen
Eppingen
 Eppstein
Eppstein
 Erbach im Odenwald
Erbach im Odenwald
 Erding
Erding
 Erdweg
Erdweg
 Erftstadt
Erftstadt
 Erfurt
Erfurt
 Erkelenz
Erkelenz
 Erkner
Erkner
 Erkrath
Erkrath
 Erlangen
Erlangen
 Erlau
Erlau
 Erlensee
Erlensee
 Ertingen
Ertingen
 Erwitte
Erwitte
 Eschborn
Eschborn
 Escheburg
Escheburg
 Eschenau
Eschenau
 Eschenbach
Eschenbach
 Eschenburg
Eschenburg
 Eschwege
Eschwege
 Eschweiler
Eschweiler
 Eslohe
Eslohe
 Espelkamp
Espelkamp
 Espenhain
Espenhain
 Essen
Essen
 Essenheim
Essenheim
 Essingen
Essingen
 Esslingen
Esslingen
 Ettenheim
Ettenheim
 Ettlingen
Ettlingen
 Euskirchen
Euskirchen
 Eutin
Eutin
 Everswinkel
Everswinkel
 Fahrdorf
Fahrdorf
 Fahrenzhausen
Fahrenzhausen
 Falkenfels
Falkenfels
 Falkenhagen
Falkenhagen
 Falkensee
Falkensee
 Farchant
Farchant
 Fassberg
Fassberg
 Fehmarn
Fehmarn
 Feldkirchen
Feldkirchen
 Feldkirchen-Westerham
Feldkirchen-Westerham
 Fellbach
Fellbach
 Feucht
Feucht
 Feuchtwangen
Feuchtwangen
 Filderstadt
Filderstadt
 Finnentrop
Finnentrop
 Finsterwalde
Finsterwalde
 Fintel
Fintel
 Flensburg
Flensburg
 Florsheim am Main
Florsheim am Main
 Floss
Floss
 Forchheim
Forchheim
 Forst
Forst
 Franken
Franken
 Frankenberg (Eder)
Frankenberg (Eder)
 Frankenthal
Frankenthal
 Frankfurt am Main
Frankfurt am Main
 Frankfurt an der Oder
Frankfurt an der Oder
 Franzburg
Franzburg
 Frechen
Frechen
 Freiberg am Neckar
Freiberg am Neckar
 Freiberg, Sachsen
Freiberg, Sachsen
 Freiburg im Breisgau
Freiburg im Breisgau
 Freigericht
Freigericht
 Freilassing
Freilassing
 Freisen
Freisen
 Freising
Freising
 Freital
Freital
 Freudenberg
Freudenberg
 Freudenstadt
Freudenstadt
 Freystadt
Freystadt
 Freyung
Freyung
 Frickenhausen am Main
Frickenhausen am Main
 Friedberg Bavaria
Friedberg Bavaria
 Friedberg Hessen
Friedberg Hessen
 Friedrichsdorf
Friedrichsdorf
 Friedrichshafen
Friedrichshafen
 Frielendorf
Frielendorf
 Friesoythe
Friesoythe
 Fritzlar
Fritzlar
 Frondenberg
Frondenberg
 Fulda
Fulda
 Furstenau
Furstenau
 Furstenfeldbruck
Furstenfeldbruck
 Furstenwalde
Furstenwalde
 Furth
Furth
 Furth im Wald
Furth im Wald
 Furtwangen
Furtwangen
 Fussen
Fussen
 Gablingen
Gablingen
 Gaggenau
Gaggenau
 Gaildorf
Gaildorf
 Ganderkesee
Ganderkesee
 Garbsen
Garbsen
 Garching
Garching
 Garching an der Alz
Garching an der Alz
 Gardelegen
Gardelegen
 Garmisch-Partenkirchen
Garmisch-Partenkirchen
 Garrel
Garrel
 Gaufelden
Gaufelden
 Gauting
Gauting
 Geeste
Geeste
 Geesthacht
Geesthacht
 Gefrees
Gefrees
 Geilenkirchen
Geilenkirchen
 Geisenheim
Geisenheim
 Geisingen
Geisingen
 Geislingen
Geislingen
 Geldern
Geldern
 Gelnhausen
Gelnhausen
 Gelsenkirchen
Gelsenkirchen
 Gengenbach
Gengenbach
 Genthin
Genthin
 Georgsmarienhutte
Georgsmarienhutte
 Gera
Gera
 Geretsried
Geretsried
 Gerlingen
Gerlingen
 Germering
Germering
 Germersheim
Germersheim
 Gernsbach
Gernsbach
 Gerolstein
Gerolstein
 Gerstetten
Gerstetten
 Gersthofen
Gersthofen
 Gescher
Gescher
 Geseke
Geseke
 Gevelsberg
Gevelsberg
 Giengen
Giengen
 Giessen
Giessen
 Gifhorn
Gifhorn
 Gilching
Gilching
 Ginsheim-Gustavsburg
Ginsheim-Gustavsburg
 Gladbeck
Gladbeck
 Gladenbach
Gladenbach
 Glauchau
Glauchau
 Glienicke/Nordbahn
Glienicke/Nordbahn
 Glinde
Glinde
 Gluckstadt
Gluckstadt
 Goch
Goch
 Golssen
Golssen
 Goppingen
Goppingen
 Gorlitz
Gorlitz
 Goslar
Goslar
 Gotha
Gotha
 Gottenheim
Gottenheim
 Gottingen
Gottingen
 Gottingen Sachsen
Gottingen Sachsen
 Gottmadingen
Gottmadingen
 Grabenstetten
Grabenstetten
 Grafelfing
Grafelfing
 Grafenau
Grafenau
 Grafenwohr
Grafenwohr
 Grafing
Grafing
 Grafschaft
Grafschaft
 Gransee
Gransee
 Grasbrunn
Grasbrunn
 Grassau
Grassau
 Grefrath
Grefrath
 Greifswald
Greifswald
 Greiz
Greiz
 Grenzach-Wyhlen
Grenzach-Wyhlen
 Greven
Greven
 Grevenbroich
Grevenbroich
 Grevesmuhlen
Grevesmuhlen
 Griesheim
Griesheim
 Grimma
Grimma
 Grobenzell
Grobenzell
 Gronau
Gronau
 Gross-Gerau
Gross-Gerau
 Gross-Umstadt
Gross-Umstadt
 Gross-Zimmern
Gross-Zimmern
 Grossbeeren
Grossbeeren
 Grossbettlingen
Grossbettlingen
 Grossebersdorf
Grossebersdorf
 Grossefehn
Grossefehn
 Grossenhain
Grossenhain
 Grossenkneten
Grossenkneten
 Grosshansdorf
Grosshansdorf
 Grossostheim
Grossostheim
 Grunberg
Grunberg
 Grundau
Grundau
 Grunhain-Beierfeld
Grunhain-Beierfeld
 Grunstadt
Grunstadt
 Grunwald
Grunwald
 Guben
Guben
 Gudensberg
Gudensberg
 Guglingen
Guglingen
 Gummersbach
Gummersbach
 Gunzburg
Gunzburg
 Gunzenhausen
Gunzenhausen
 Gusenburg
Gusenburg
 Gustrow
Gustrow
 Gutenzell-Hurbel
Gutenzell-Hurbel
 Gutersloh
Gutersloh
 Haan
Haan
 Haar
Haar
 Hachenburg
Hachenburg
 Hagen
Hagen
 Hagenow
Hagenow
 Hahn bei Marienberg
Hahn bei Marienberg
 Haiger
Haiger
 Haigerloch
Haigerloch
 Haina
Haina
 Hainichen
Hainichen
 Halberstadt
Halberstadt
 Halblech
Halblech
 Haldensleben
Haldensleben
 Hallbergmoos
Hallbergmoos
 Halle
Halle
 Hallerndorf
Hallerndorf
 Hallstadt
Hallstadt
 Haltern
Haltern
 Hamburg
Hamburg
 Hamelin
Hamelin
 Hamm
Hamm
 Hammelburg
Hammelburg
 Hammersbach
Hammersbach
 Hamminkeln
Hamminkeln
 Hanau
Hanau
 Hann. Munden
Hann. Munden
 Hannover
Hannover
 Hansestadt Salzwedel
Hansestadt Salzwedel
 Harburg
Harburg
 Hardegsen
Hardegsen
 Hardheim
Hardheim
 Haren
Haren
 Harrislee
Harrislee
 Harsefeld
Harsefeld
 Harsewinkel
Harsewinkel
 Harsum
Harsum
 Hartheim
Hartheim
 Hasbergen
Hasbergen
 Haselunne
Haselunne
 Haslach im Kinzigtal
Haslach im Kinzigtal
 Hassfurt
Hassfurt
 Hassloch
Hassloch
 Hattersheim am Main
Hattersheim am Main
 Hattert
Hattert
 Hattingen
Hattingen
 Hauzenberg
Hauzenberg
 Hechingen
Hechingen
 Heddesheim
Heddesheim
 Heeslingen
Heeslingen
 Heide
Heide
 Heideck
Heideck
 Heidelberg
Heidelberg
 Heidenau
Heidenau
 Heidenheim
Heidenheim
 Heilbad Heiligenstadt
Heilbad Heiligenstadt
 Heilbronn
Heilbronn
 Heiligenhafen
Heiligenhafen
 Heiligenhaus
Heiligenhaus
 Heiligenstadt
Heiligenstadt
 Heilsbronn
Heilsbronn
 Heinersreuth
Heinersreuth
 Heinsberg
Heinsberg
 Helferskirchen
Helferskirchen
 Helmstadt
Helmstadt
 Helmstedt
Helmstedt
 Hemer
Hemer
 Hemmingen
Hemmingen
 Hennef
Hennef
 Hennigsdorf
Hennigsdorf
 Henstedt-Ulzburg
Henstedt-Ulzburg
 Heppenheim
Heppenheim
 Herbertingen
Herbertingen
 Herborn
Herborn
 Herbrechtingen
Herbrechtingen
 Herdecke
Herdecke
 Herford
Herford
 Hergatz
Hergatz
 Hermannsburg
Hermannsburg
 Hermsdorf
Hermsdorf
 Herne
Herne
 Herrenberg
Herrenberg
 Herrsching
Herrsching
 Hersbruck
Hersbruck
 Herschbach
Herschbach
 Herten
Herten
 Herxheim
Herxheim
 Herzberg
Herzberg
 Herzberg am Harz
Herzberg am Harz
 Herzebrock-Clarholz
Herzebrock-Clarholz
 Herzogenaurach
Herzogenaurach
 Herzogenrath
Herzogenrath
 Hessisch Oldendorf
Hessisch Oldendorf
 Hettstedt
Hettstedt
 Heusenstamm
Heusenstamm
 Heustreu
Heustreu
 Hiddenhausen
Hiddenhausen
 Hilchenbach
Hilchenbach
 Hildburghausen
Hildburghausen
 Hilden
Hilden
 Hildesheim
Hildesheim
 Hilpoltstein
Hilpoltstein
 Hirschberg
Hirschberg
 Hochberg
Hochberg
 Hochheim am Main
Hochheim am Main
 Hochstadt
Hochstadt
 Hockenheim
Hockenheim
 Hof
Hof
 Hofheim
Hofheim
 Hohen Neuendorf
Hohen Neuendorf
 Hohenfels
Hohenfels
 Hohenkirchen-Siegertsbrunn
Hohenkirchen-Siegertsbrunn
 Hohenlockstedt
Hohenlockstedt
 Hohenstein
Hohenstein
 Hohenstein-Ernstthal
Hohenstein-Ernstthal
 Hohentengen am Hochrhein
Hohentengen am Hochrhein
 Hohn
Hohn
 Hohr-Grenzhausen
Hohr-Grenzhausen
 Hoisdorf
Hoisdorf
 Holm
Holm
 Holzgerlingen
Holzgerlingen
 Holzkirchen
Holzkirchen
 Holzminden
Holzminden
 Holzwickede
Holzwickede
 Homburg
Homburg
 Hopferau
Hopferau
 Hoppegarten
Hoppegarten
 Hoppstadten-Weiersbach
Hoppstadten-Weiersbach
 Horb am Neckar
Horb am Neckar
 Horn-Bad Meinberg
Horn-Bad Meinberg
 Hornberg
Hornberg
 Horstel
Horstel
 Horstmar
Horstmar
 Hovelhof
Hovelhof
 Hoxter
Hoxter
 Hoyerswerda
Hoyerswerda
 Huckelhoven
Huckelhoven
 Huckeswagen
Huckeswagen
 Hullhorst
Hullhorst
 Hunfeld
Hunfeld
 Hungen
Hungen
 Hunxe
Hunxe
 Hurth
Hurth
 Husum
Husum
 Hutschenhausen
Hutschenhausen
 Ibbenburen
Ibbenburen
 Idar-Oberstein
Idar-Oberstein
 Idstein
Idstein
 Illertissen
Illertissen
 Illingen
Illingen
 Ilmenau
Ilmenau
 Ilsenburg
Ilsenburg
 Ilsfeld
Ilsfeld
 Ilshofen
Ilshofen
 Immelborn
Immelborn
 Immenstaad
Immenstaad
 Immenstadt
Immenstadt
 Ingelfingen
Ingelfingen
 Ingelheim am Rhein
Ingelheim am Rhein
 Ingolstadt
Ingolstadt
 Iphofen
Iphofen
 Iserlohn
Iserlohn
 Isernhagen
Isernhagen
 Ismaning
Ismaning
 Isny im Allgau
Isny im Allgau
 Ispringen
Ispringen
 Isselburg
Isselburg
 Issum
Issum
 Itzehoe
Itzehoe
 Jachenau
Jachenau
 Jena
Jena
 Jettingen-Scheppach
Jettingen-Scheppach
 Jever
Jever
 Jork
Jork
 Julich
Julich
 Kaarst
Kaarst
 Kahl am Main
Kahl am Main
 Kaiserslautern
Kaiserslautern
 Kalefeld
Kalefeld
 Kalkar
Kalkar
 Kall
Kall
 Kaltenkirchen
Kaltenkirchen
 Kamen
Kamen
 Kamenz
Kamenz
 Kamp-Lintfort
Kamp-Lintfort
 Kandern
Kandern
 Karben
Karben
 Karlsbad
Karlsbad
 Karlsdorf-Neuthard
Karlsdorf-Neuthard
 Karlsfeld
Karlsfeld
 Karlsruhe
Karlsruhe
 Karlstadt am Main
Karlstadt am Main
 Karwe
Karwe
 Kassel
Kassel
 Kaufbeuren
Kaufbeuren
 Kaufering
Kaufering
 Köln
Köln
 Kehl
Kehl
 Kelheim
Kelheim
 Kelkheim (Taunus)
Kelkheim (Taunus)
 Kelsterbach
Kelsterbach
 Keltern
Keltern
 Kempen
Kempen
 Kempten
Kempten
 Kenzingen
Kenzingen
 Kernen
Kernen
 Kerpen
Kerpen
 Kesselsdorf
Kesselsdorf
 Kettershausen
Kettershausen
 Kevelaer
Kevelaer
 Kiel
Kiel
 Kierspe
Kierspe
 Kirchheim bei Munchen
Kirchheim bei Munchen
 Kirchheim unter Teck
Kirchheim unter Teck
 Kirchheimbolanden
Kirchheimbolanden
 Kirchlengern
Kirchlengern
 Kirchseeon
Kirchseeon
 Kirchzarten
Kirchzarten
 Kirkel
Kirkel
 Kirn
Kirn
 Kissing
Kissing
 Kitzingen
Kitzingen
 Kleinmachnow
Kleinmachnow
 Kleinostheim
Kleinostheim
 Kleve
Kleve
 Klingenberg am Main
Klingenberg am Main
 Klipphausen
Klipphausen
 Kloster Lehnin
Kloster Lehnin
 Koblenz
Koblenz
 Kolbermoor
Kolbermoor
 Kolkwitz
Kolkwitz
 Kolleda
Kolleda
 Kollnburg
Kollnburg
 Konigs Wusterhausen
Konigs Wusterhausen
 Konigsbach-Stein
Konigsbach-Stein
 Konigsberg
Konigsberg
 Konigsbruck
Konigsbruck
 Konigsbrunn
Konigsbrunn
 Konigslutter
Konigslutter
 Konigstein im Taunus
Konigstein im Taunus
 Konigswinter
Konigswinter
 Konstanz
Konstanz
 Korbach
Korbach
 Kordel
Kordel
 Korntal-Munchingen
Korntal-Munchingen
 Kornwestheim
Kornwestheim
 Korschenbroich
Korschenbroich
 Kothen
Kothen
 Kraichtal
Kraichtal
 Kranenburg
Kranenburg
 Krefeld
Krefeld
 Kremmen
Kremmen
 Kreuztal
Kreuztal
 Kriftel
Kriftel
 Krolpa
Krolpa
 Kronach
Kronach
 Kronau
Kronau
 Kronberg
Kronberg
 Kronshagen
Kronshagen
 Kropp
Kropp
 Krumbach
Krumbach
 Kuhlungsborn
Kuhlungsborn
 Kulmbach
Kulmbach
 Kummersbruck
Kummersbruck
 Kunzell
Kunzell
 Kunzelsau
Kunzelsau
 Kurten
Kurten
 Kusel
Kusel
 Kussaberg
Kussaberg
 Kusterdingen
Kusterdingen
 Laatzen
Laatzen
 Lachendorf
Lachendorf
 Ladenburg
Ladenburg
 Lage
Lage
 Lahnstein
Lahnstein
 Lahr
Lahr
 Laichingen
Laichingen
 Lam
Lam
 Lampertheim
Lampertheim
 Landau
Landau
 Landau an der Isar
Landau an der Isar
 Landsberg
Landsberg
 Landsberg am Lech
Landsberg am Lech
 Landshut
Landshut
 Landstuhl
Landstuhl
 Langen (Hessen)
Langen (Hessen)
 Langenau
Langenau
 Langenfeld
Langenfeld
 Langenhagen
Langenhagen
 Langenselbold
Langenselbold
 Langensendelbach
Langensendelbach
 Langewiesen
Langewiesen
 Langgons
Langgons
 Laubach
Laubach
 Lauchhammer
Lauchhammer
 Lauchheim
Lauchheim
 Lauda-Konigshofen
Lauda-Konigshofen
 Lauenburg Elbe
Lauenburg Elbe
 Lauf an der Pegnitz
Lauf an der Pegnitz
 Lauffen am Neckar
Lauffen am Neckar
 Laupheim
Laupheim
 Lausitz
Lausitz
 Lauterbach
Lauterbach
 Lebach
Lebach
 Leer
Leer
 Leeste
Leeste
 Lehrte
Lehrte
 Leichlingen
Leichlingen
 Leimen
Leimen
 Leinburg
Leinburg
 Leinfelden-Echterdingen
Leinfelden-Echterdingen
 Leingarten
Leingarten
 Leipzig
Leipzig
 Lemgo
Lemgo
 Lengede
Lengede
 Lengerich
Lengerich
 Lenggries
Lenggries
 Lennestadt
Lennestadt
 Lensahn
Lensahn
 Lenzkirch
Lenzkirch
 Leonberg
Leonberg
 Leopoldshohe
Leopoldshohe
 Leutkirch im Allgau
Leutkirch im Allgau
 Leverkusen
Leverkusen
 Lich
Lich
 Lichtenau
Lichtenau
 Lichtenfels
Lichtenfels
 Liebenburg
Liebenburg
 Lilienthal
Lilienthal
 Limbach-Oberfrohna
Limbach-Oberfrohna
 Limburg
Limburg
 Limburgerhof
Limburgerhof
 Lindau
Lindau
 Lindenberg
Lindenberg
 Lindenberg im Allgau
Lindenberg im Allgau
 Lindlar
Lindlar
 Lingen
Lingen
 Linnich
Linnich
 Lippoldsberg
Lippoldsberg
 Lippstadt
Lippstadt
 Lobau
Lobau
 Lohfelden
Lohfelden
 Lohmar
Lohmar
 Lohne
Lohne
 Lohr
Lohr
 Lohra
Lohra
 Lommatzsch
Lommatzsch
 Loningen
Loningen
 Lorch
Lorch
 Lorrach
Lorrach
 Losheim am See
Losheim am See
 Lotte
Lotte
 Loxstedt
Loxstedt
 Lubbecke
Lubbecke
 Lubben
Lubben
 Lubbenau
Lubbenau
 Lubeck
Lubeck
 Luchow
Luchow
 Luckenwalde
Luckenwalde
 Ludenscheid
Ludenscheid
 Ludinghausen
Ludinghausen
 Ludwigsburg
Ludwigsburg
 Ludwigsfelde
Ludwigsfelde
 Ludwigshafen
Ludwigshafen
 Luneburg
Luneburg
 Lunen
Lunen
 Lutjenburg
Lutjenburg
 Lutzelbach
Lutzelbach
 Lutzerath
Lutzerath
 Magdeburg
Magdeburg
 Mainburg
Mainburg
 Maintal
Maintal
 Mainz
Mainz
 Maisach
Maisach
 Malchow
Malchow
 Mallersdorf-Pfaffenberg
Mallersdorf-Pfaffenberg
 Malsch
Malsch
 Malsfeld
Malsfeld
 Mammendorf
Mammendorf
 Manching
Manching
 Manheim
Manheim
 Mannheim
Mannheim
 Marbach am Neckar
Marbach am Neckar
 Marburg
Marburg
 Marienberg
Marienberg
 Markdorf
Markdorf
 Markgroningen
Markgroningen
 Markkleeberg
Markkleeberg
 Markranstadt
Markranstadt
 Markt Schwaben
Markt Schwaben
 Marktheidenfeld
Marktheidenfeld
 Marktoberdorf
Marktoberdorf
 Marktredwitz
Marktredwitz
 Marl
Marl
 Maroldsweisach
Maroldsweisach
 Marpingen
Marpingen
 Marsberg
Marsberg
 Martinsried
Martinsried
 Marwitz
Marwitz
 Maulburg
Maulburg
 Maxhutte-Haidhof
Maxhutte-Haidhof
 Mayen
Mayen
 Mechernich
Mechernich
 Meckenbeuren
Meckenbeuren
 Meckenheim
Meckenheim
 Medebach
Medebach
 Meerane
Meerane
 Meerbusch
Meerbusch
 Mehlingen
Mehlingen
 Meinersen
Meinersen
 Meinerzhagen
Meinerzhagen
 Meiningen
Meiningen
 Meisenheim
Meisenheim
 Meissen
Meissen
 Meitingen
Meitingen
 Meldorf
Meldorf
 Melle
Melle
 Mellrichstadt
Mellrichstadt
 Melsungen
Melsungen
 Memmingen
Memmingen
 Menden
Menden
 Meppen
Meppen
 Merseburg
Merseburg
 Mertingen
Mertingen
 Merzig
Merzig
 Meschede
Meschede
 Messkirch
Messkirch
 Mettlach
Mettlach
 Mettmann
Mettmann
 Metzingen
Metzingen
 Meudt
Meudt
 Michelstadt
Michelstadt
 Michendorf
Michendorf
 Miesbach
Miesbach
 Mildstedt
Mildstedt
 Miltenberg
Miltenberg
 Mindelheim
Mindelheim
 Minden
Minden
 Mittenwald
Mittenwald
 Mittweida
Mittweida
 Mockmuhl
Mockmuhl
 Moers-Vinn
Moers-Vinn
 Mohnesee
Mohnesee
 Molbergen
Molbergen
 Molln
Molln
 Mombris
Mombris
 Monchberg
Monchberg
 Monchengladbach
Monchengladbach
 Monheim am Rhein
Monheim am Rhein
 Monschau
Monschau
 Monsheim
Monsheim
 Montabaur
Montabaur
 Moormerland
Moormerland
 Moosburg
Moosburg
 Morbach
Morbach
 Morfelden-Walldorf
Morfelden-Walldorf
 Morsbach
Morsbach
 Mosbach
Mosbach
 Mossingen
Mossingen
 Much
Much
 Mucke
Mucke
 Muhlacker
Muhlacker
 Muhldorf
Muhldorf
 Muhlenbecker Land
Muhlenbecker Land
 Muhlhausen
Muhlhausen
 Muhlheim am Main
Muhlheim am Main
 Mulda
Mulda
 Mulfingen
Mulfingen
 Mulheim
Mulheim
 Mulheim (Moselle)
Mulheim (Moselle)
 Mulheim-Karlich
Mulheim-Karlich
 Mullheim
Mullheim
 Mulsen
Mulsen
 Munchberg
Munchberg
 Muncheberg
Muncheberg
 Munchen
Munchen
 Munich
Munich
 Munschwitz
Munschwitz
 Munsingen
Munsingen
 Munster
Munster
 Munster, Hesse
Munster, Hesse
 Munster, Lower Saxony
Munster, Lower Saxony
 Murnau am Staffelsee
Murnau am Staffelsee
 Mutterstadt
Mutterstadt
 Nabburg
Nabburg
 Nagold
Nagold
 Naila
Naila
 Nauen
Nauen
 Naumburg
Naumburg
 Neckargemund
Neckargemund
 Neckarsulm
Neckarsulm
 Neckartailfingen
Neckartailfingen
 Neckartenzlingen
Neckartenzlingen
 Neidenbach
Neidenbach
 Neresheim
Neresheim
 Nersingen
Nersingen
 Netphen
Netphen
 Nettetal
Nettetal
 Neu Wulmstorf
Neu Wulmstorf
 Neu-Anspach
Neu-Anspach
 Neu-Isenburg
Neu-Isenburg
 Neu-Ulm
Neu-Ulm
 Neubiberg
Neubiberg
 Neubrandenburg
Neubrandenburg
 Neuburg an der Donau
Neuburg an der Donau
 Neuendettelsau
Neuendettelsau
 Neuenhagen
Neuenhagen
 Neuenhaus
Neuenhaus
 Neuenkirchen
Neuenkirchen
 Neuenrade
Neuenrade
 Neuenstein
Neuenstein
 Neufahrn bei Freising
Neufahrn bei Freising
 Neuhaus am Rennweg
Neuhaus am Rennweg
 Neuhausen auf den Fildern
Neuhausen auf den Fildern
 Neukirchen-Vluyn
Neukirchen-Vluyn
 Neumarkt in der Oberpfalz
Neumarkt in der Oberpfalz
 Neumunster
Neumunster
 Neunburg vorm Wald
Neunburg vorm Wald
 Neunkirchen
Neunkirchen
 Neunkirchen, North Rhine-Westphalia
Neunkirchen, North Rhine-Westphalia
 Neunkirchen, Saarland
Neunkirchen, Saarland
 Neunkirchen-Seelscheid
Neunkirchen-Seelscheid
 Neuruppin
Neuruppin
 Neusass
Neusass
 Neuss
Neuss
 Neustadt
Neustadt
 Neustadt am Rubenberge
Neustadt am Rubenberge
 Neustadt an der Aisch
Neustadt an der Aisch
 Neustadt an der Donau
Neustadt an der Donau
 Neustadt an der Orla
Neustadt an der Orla
 Neustadt, Bavaria
Neustadt, Bavaria
 Neustadt, Rhineland-Palatinate
Neustadt, Rhineland-Palatinate
 Neustadt, Schleswig-Holstein
Neustadt, Schleswig-Holstein
 Neustrelitz
Neustrelitz
 Neutraubling
Neutraubling
 Neuwied
Neuwied
 Nidda
Nidda
 Nidderau
Nidderau
 Niebull
Niebull
 Nieder-Olm
Nieder-Olm
 Niedereschach
Niedereschach
 Niederkassel
Niederkassel
 Niederkruchten
Niederkruchten
 Niedernberg
Niedernberg
 Niedernhausen
Niedernhausen
 Niederviehbach
Niederviehbach
 Niefern-Oschelbronn
Niefern-Oschelbronn
 Nienburg
Nienburg
 Norden
Norden
 Nordenham
Nordenham
 Norderstedt
Norderstedt
 Nordhausen
Nordhausen
 Nordhorn
Nordhorn
 Nordkirchen
Nordkirchen
 Nordlingen
Nordlingen
 Northeim
Northeim
 Nortrup
Nortrup
 Norvenich
Norvenich
 Nottuln
Nottuln
 Numbrecht
Numbrecht
 Nunchritz
Nunchritz
 Nuremberg
Nuremberg
 Nurtingen
Nurtingen
 Nussloch
Nussloch
 Nuthetal
Nuthetal
 Ober-Olm
Ober-Olm
 Ober-Ramstadt
Ober-Ramstadt
 Oberammergau
Oberammergau
 Oberding
Oberding
 Oberessendorf
Oberessendorf
 Oberhaching
Oberhaching
 Oberhausen
Oberhausen
 Oberhausen-Rheinhausen
Oberhausen-Rheinhausen
 Oberkirch
Oberkirch
 Oberkochen
Oberkochen
 Obernburg
Obernburg
 Oberndorf
Oberndorf
 Oberndorf am Lech
Oberndorf am Lech
 Oberrot
Oberrot
 Oberschleissheim
Oberschleissheim
 Oberstaufen
Oberstaufen
 Oberstdorf
Oberstdorf
 Obersulm
Obersulm
 Obertshausen
Obertshausen
 Oberursel
Oberursel
 Ochsenfurt
Ochsenfurt
 Odelzhausen
Odelzhausen
 Oelde
Oelde
 Oer-Erkenschwick
Oer-Erkenschwick
 Oestrich-Winkel
Oestrich-Winkel
 Oettingen in Bayern
Oettingen in Bayern
 Offenbach
Offenbach
 Offenburg
Offenburg
 Ohlstadt
Ohlstadt
 Ohringen
Ohringen
 Olbernhau
Olbernhau
 Olching
Olching
 Oldenburg
Oldenburg
 Olfen
Olfen
 Olpe
Olpe
 Olsberg
Olsberg
 Oppenweiler
Oppenweiler
 Oranienburg
Oranienburg
 Ortenberg
Ortenberg
 Oschatz
Oschatz
 Oschersleben
Oschersleben
 Osnabruck
Osnabruck
 Osterburken
Osterburken
 Osterby
Osterby
 Osterholz-Scharmbeck
Osterholz-Scharmbeck
 Osterode am Harz
Osterode am Harz
 Ostfildern
Ostfildern
 Ostrach
Ostrach
 Ottendorf-Okrilla
Ottendorf-Okrilla
 Ottersberg
Ottersberg
 Ottobeuren
Ottobeuren
 Ottobrunn
Ottobrunn
 Ottweiler
Ottweiler
 Overath
Overath
 Owen
Owen
 Oyten
Oyten
 Paderborn
Paderborn
 Papenburg
Papenburg
 Parchim
Parchim
 Parkstein
Parkstein
 Parsberg
Parsberg
 Pasewalk
Pasewalk
 Passau
Passau
 Pegnitz
Pegnitz
 Peine
Peine
 Peissenberg
Peissenberg
 Peiting
Peiting
 Penzberg
Penzberg
 Perl
Perl
 Perleberg
Perleberg
 Petersaurach
Petersaurach
 Petershagen
Petershagen
 Pfaffenhofen an der Ilm
Pfaffenhofen an der Ilm
 Pfarrkirchen
Pfarrkirchen
 Pfinztal
Pfinztal
 Pforzheim
Pforzheim
 Pfronten
Pfronten
 Pfullendorf
Pfullendorf
 Pfullingen
Pfullingen
 Pfungstadt
Pfungstadt
 Philippsburg
Philippsburg
 Pilsach
Pilsach
 Pinneberg
Pinneberg
 Pirmasens
Pirmasens
 Planegg
Planegg
 Plattling
Plattling
 Plau am See
Plau am See
 Plauen
Plauen
 Plettenberg
Plettenberg
 Pliezhausen
Pliezhausen
 Plochingen
Plochingen
 Plon
Plon
 Pohlheim
Pohlheim
 Poing
Poing
 Porta Westfalica
Porta Westfalica
 Postbauer-Heng
Postbauer-Heng
 Potsdam
Potsdam
 Pottum
Pottum
 Preetz
Preetz
 Prenzlau
Prenzlau
 Prichsenstadt
Prichsenstadt
 Prien am Chiemsee
Prien am Chiemsee
 Pritzwalk
Pritzwalk
 Prum
Prum
 Puchheim
Puchheim
 Pulheim
Pulheim
 Pullach
Pullach
 Putbus
Putbus
 Quakenbruck
Quakenbruck
 Quedlinburg
Quedlinburg
 Queidersbach
Queidersbach
 Querfurt
Querfurt
 Quickborn
Quickborn
 Radeberg
Radeberg
 Radebeul
Radebeul
 Radevormwald
Radevormwald
 Radolfzell
Radolfzell
 Raesfeld
Raesfeld
 Rahden
Rahden
 Rain
Rain
 Raisdorf
Raisdorf
 Ramstein-Miesenbach
Ramstein-Miesenbach
 Rangendingen
Rangendingen
 Rantum
Rantum
 Rastatt
Rastatt
 Rastede
Rastede
 Ratekau
Ratekau
 Ratheim
Ratheim
 Rathenow
Rathenow
 Ratingen
Ratingen
 Ratzeburg
Ratzeburg
 Raubling
Raubling
 Raunheim
Raunheim
 Ravensburg
Ravensburg
 Recke
Recke
 Recklinghausen
Recklinghausen
 Rednitzhembach
Rednitzhembach
 Rees
Rees
 Regen
Regen
 Regensburg
Regensburg
 Regenstauf
Regenstauf
 Rehau
Rehau
 Rehburg-Loccum
Rehburg-Loccum
 Reichelsheim
Reichelsheim
 Reichenbach
Reichenbach
 Reichenbach im Vogtland
Reichenbach im Vogtland
 Reichertshofen
Reichertshofen
 Reichshof
Reichshof
 Reinbek
Reinbek
 Reinfeld
Reinfeld
 Reiskirchen
Reiskirchen
 Reken
Reken
 Rellingen
Rellingen
 Remagen
Remagen
 Remscheid
Remscheid
 Remseck
Remseck
 Remshalden
Remshalden
 Renchen
Renchen
 Rendsburg
Rendsburg
 Rennerod
Rennerod
 Renningen
Renningen
 Reutlingen
Reutlingen
 Rheda-Wiedenbruck
Rheda-Wiedenbruck
 Rheinbach
Rheinbach
 Rheinberg
Rheinberg
 Rheine
Rheine
 Rheinfelden
Rheinfelden
 Rheinstetten
Rheinstetten
 Rheinzabern
Rheinzabern
 Ribnitz-Damgarten
Ribnitz-Damgarten
 Riedlingen
Riedlingen
 Riedstadt
Riedstadt
 Riesa
Riesa
 Rietberg
Rietberg
 Rietheim-Weilheim
Rietheim-Weilheim
 Rinteln
Rinteln
 Rockenberg
Rockenberg
 Rodenbach
Rodenbach
 Rodental
Rodental
 Rodermark
Rodermark
 Rodgau
Rodgau
 Roding
Roding
 Roetgen
Roetgen
 Rohrsdorf
Rohrsdorf
 Rommerskirchen
Rommerskirchen
 Ronnenberg
Ronnenberg
 Rosengarten
Rosengarten
 Rosenheim
Rosenheim
 Rosrath
Rosrath
 Rossdorf
Rossdorf
 Rostock
Rostock
 Rotenburg
Rotenburg
 Roth
Roth
 Rothenburg
Rothenburg
 Rottenbach
Rottenbach
 Rottenburg
Rottenburg
 Rottendorf
Rottendorf
 Rottweil
Rottweil
 Rudolstadt
Rudolstadt
 Ruhstorf an der Rott
Ruhstorf an der Rott
 Russelsheim
Russelsheim
 Rust
Rust
 Rutesheim
Rutesheim
 Ruthen
Ruthen
 Saalfeld
Saalfeld
 Saarbrucken
Saarbrucken
 Saarlouis
Saarlouis
 Saarwellingen
Saarwellingen
 Sachsenheim
Sachsenheim
 Sailauf
Sailauf
 Salach
Salach
 Salem
Salem
 Salzbergen
Salzbergen
 Salzburg
Salzburg
 Salzgitter
Salzgitter
 Salzhemmendorf
Salzhemmendorf
 Salzkotten
Salzkotten
 Sande
Sande
 Sangerhausen
Sangerhausen
 Sankt Andreasberg
Sankt Andreasberg
 Sankt Augustin
Sankt Augustin
 Sankt Blasien
Sankt Blasien
 Sankt Georgen im Schwarzwald
Sankt Georgen im Schwarzwald
 Sankt Ingbert
Sankt Ingbert
 Sankt Leon-Rot
Sankt Leon-Rot
 Sankt Peter-Ording
Sankt Peter-Ording
 Sankt Wendel
Sankt Wendel
 Sankt Wolfgang
Sankt Wolfgang
 Sarstedt
Sarstedt
 Sassenberg
Sassenberg
 Sassenburg
Sassenburg
 Sassnitz
Sassnitz
 Saulgau
Saulgau
 Saulheim
Saulheim
 Schalksmuhle
Schalksmuhle
 Scheessel
Scheessel
 Scheidegg
Scheidegg
 Schenefeld
Schenefeld
 Schierling
Schierling
 Schifferstadt
Schifferstadt
 Schiffweiler
Schiffweiler
 Schiltach
Schiltach
 Schkeuditz
Schkeuditz
 Schlangen
Schlangen
 Schleiden
Schleiden
 Schleiz
Schleiz
 Schleswig
Schleswig
 Schloss Holte-Stukenbrock
Schloss Holte-Stukenbrock
 Schluchtern
Schluchtern
 Schlusselfeld
Schlusselfeld
 Schmalkalden
Schmalkalden
 Schmallenberg
Schmallenberg
 Schmelz
Schmelz
 Schmolln
Schmolln
 Schnaittenbach
Schnaittenbach
 Schneverdingen
Schneverdingen
 Schoenaich
Schoenaich
 Schonebeck
Schonebeck
 Schonefeld
Schonefeld
 Schongau
Schongau
 Schontal
Schontal
 Schopfheim
Schopfheim
 Schopfloch
Schopfloch
 Schoppenstedt
Schoppenstedt
 Schorfheide
Schorfheide
 Schorndorf
Schorndorf
 Schortens
Schortens
 Schramberg
Schramberg
 Schriesheim
Schriesheim
 Schrobenhausen
Schrobenhausen
 Schulp
Schulp
 Schutterwald
Schutterwald
 Schuttorf
Schuttorf
 Schwabach
Schwabach
 Schwabisch Gmund
Schwabisch Gmund
 Schwabisch Hall
Schwabisch Hall
 Schwabmunchen
Schwabmunchen
 Schwaigern
Schwaigern
 Schwaikheim
Schwaikheim
 Schwalbach
Schwalbach
 Schwalmstadt
Schwalmstadt
 Schwalmtal
Schwalmtal
 Schwanau
Schwanau
 Schwandorf
Schwandorf
 Schwanewede
Schwanewede
 Schwarzenbek
Schwarzenbek
 Schwarzenberg
Schwarzenberg
 Schwarzenbruck
Schwarzenbruck
 Schwedt
Schwedt
 Schweinfurt
Schweinfurt
 Schwelm
Schwelm
 Schwenningen
Schwenningen
 Schwerin
Schwerin
 Schwerte
Schwerte
 Schwetzingen
Schwetzingen
 Schwieberdingen
Schwieberdingen
 Seebruck
Seebruck
 Seefeld
Seefeld
 Seehausen am Staffelsee
Seehausen am Staffelsee
 Seeheim-Jugenheim
Seeheim-Jugenheim
 Seelze
Seelze
 Seesen
Seesen
 Seevetal
Seevetal
 Sehnde
Sehnde
 Selb
Selb
 Seligenstadt
Seligenstadt
 Selters
Selters
 Selters(Westerwald)
Selters(Westerwald)
 Sembach
Sembach
 Senden
Senden
 Sendenhorst
Sendenhorst
 Senftenberg
Senftenberg
 Sengenthal
Sengenthal
 Siegburg
Siegburg
 Siegen
Siegen
 Siegsdorf
Siegsdorf
 Sigmaringen
Sigmaringen
 Simbach
Simbach
 Simmerath
Simmerath
 Simmern
Simmern
 Sindelfingen
Sindelfingen
 Singen
Singen
 Sinsheim
Sinsheim
 Sinzig
Sinzig
 Sittensen
Sittensen
 Sobernheim
Sobernheim
 Soest
Soest
 Solingen
Solingen
 Solms
Solms
 Soltau
Soltau
 Sommerda
Sommerda
 Sondershausen
Sondershausen
 Sonneberg
Sonneberg
 Sonthofen
Sonthofen
 Soyen
Soyen
 Spaichingen
Spaichingen
 Spangdahlem
Spangdahlem
 Spelle
Spelle
 Speyer
Speyer
 Spremberg
Spremberg
 Springe
Springe
 Sprockhovel
Sprockhovel
 Stade
Stade
 Stadecken-Elsheim
Stadecken-Elsheim
 Stadtallendorf
Stadtallendorf
 Stadthagen
Stadthagen
 Stadtkyll
Stadtkyll
 Stadtlohn
Stadtlohn
 Staffelstein
Staffelstein
 Stahnsdorf
Stahnsdorf
 Stamsried
Stamsried
 Starnberg
Starnberg
 Stassfurt
Stassfurt
 Staufen
Staufen
 Stein
Stein
 Steinau an der Strasse
Steinau an der Strasse
 Steinen
Steinen
 Steinfeld
Steinfeld
 Steinfurt
Steinfurt
 Steinhagen
Steinhagen
 Steinheim
Steinheim
 Steinheim am Albuch
Steinheim am Albuch
 Steinheim an der Murr
Steinheim an der Murr
 Steinwiesen
Steinwiesen
 Stelle
Stelle
 Stemwede
Stemwede
 Stendal
Stendal
 Stephanskirchen
Stephanskirchen
 Stetten
Stetten
 Stetten am kalten Markt
Stetten am kalten Markt
 Stockach
Stockach
 Stockelsdorf
Stockelsdorf
 Stockheim
Stockheim
 Stockstadt am Main
Stockstadt am Main
 Stolberg (Rhineland)
Stolberg (Rhineland)
 Stolzenau
Stolzenau
 Stotternheim
Stotternheim
 Straelen
Straelen
 Stralsund
Stralsund
 Straubenhardt
Straubenhardt
 Straubing
Straubing
 Strausberg
Strausberg
 Stromberg
Stromberg
 Strullendorf
Strullendorf
 Stubenberg
Stubenberg
 Stuhlingen
Stuhlingen
 Stuhr
Stuhr
 Stutensee
Stutensee
 Stuttgart
Stuttgart
 Sudbrookmerland
Sudbrookmerland
 Suhl
Suhl
 Sulingen
Sulingen
 Sulz
Sulz
 Sulzbach
Sulzbach
 Sulzbach-Rosenberg
Sulzbach-Rosenberg
 Sundern
Sundern
 Sussen
Sussen
 Swisttal
Swisttal
 Syke
Syke
 Tamm
Tamm
 Tangstedt
Tangstedt
 Tann
Tann
 Tauberbischofsheim
Tauberbischofsheim
 Taufkirchen
Taufkirchen
 Taunusstein
Taunusstein
 Tecklenburg
Tecklenburg
 Telgte
Telgte
 Teltow
Teltow
 Templin
Templin
 Teningen
Teningen
 Teterow
Teterow
 Tettau
Tettau
 Tettnang
Tettnang
 Teunz
Teunz
 Thale
Thale
 Thalmassing
Thalmassing
 Tiefenbach
Tiefenbach
 Timmendorfer Strand
Timmendorfer Strand
 Tirschenreuth
Tirschenreuth
 Titisee-Neustadt
Titisee-Neustadt
 Tittling
Tittling
 Tittmoning
Tittmoning
 Toging am Inn
Toging am Inn
 Tonisvorst
Tonisvorst
 Tonning
Tonning
 Torgau
Torgau
 Tornesch
Tornesch
 Tostedt
Tostedt
 Traunreut
Traunreut
 Traunstein
Traunstein
 Trebur
Trebur
 Treuchtlingen
Treuchtlingen
 Treuen
Treuen
 Triberg
Triberg
 Trier
Trier
 Triesdorf
Triesdorf
 Troisdorf
Troisdorf
 Trossingen
Trossingen
 Trostberg
Trostberg
 Tubingen
Tubingen
 Turkheim
Turkheim
 Tuttlingen
Tuttlingen
 Tutzing
Tutzing
 Twist
Twist
 Twistringen
Twistringen
 Ubach-Palenberg
Ubach-Palenberg
 Uberlingen
Uberlingen
 Ubstadt-Weiher
Ubstadt-Weiher
 Ueckermunde
Ueckermunde
 Uedem
Uedem
 Uelzen
Uelzen
 Uetersen
Uetersen
 Uetze
Uetze
 Uhingen
Uhingen
 Uhldingen-Muhlhofen
Uhldingen-Muhlhofen
 Ulm
Ulm
 Unna
Unna
 Unterfohring
Unterfohring
 Untergruppenbach
Untergruppenbach
 Unterhaching
Unterhaching
 Unterschleissheim
Unterschleissheim
 Uplengen
Uplengen
 Usingen
Usingen
 Uslar
Uslar
 Vaihingen an der Enz
Vaihingen an der Enz
 Vallendar
Vallendar
 Valley
Valley
 Varel
Varel
 Vaterstetten
Vaterstetten
 Vechelde
Vechelde
 Vechta
Vechta
 Velbert
Velbert
 Velen
Velen
 Vellmar
Vellmar
 Verden
Verden
 Verl
Verl
 Versmold
Versmold
 Vienenburg
Vienenburg
 Viernheim
Viernheim
 Viersen
Viersen
 Villingen-Schwenningen
Villingen-Schwenningen
 Vilsbiburg
Vilsbiburg
 Vilseck
Vilseck
 Vilshofen an der Donau
Vilshofen an der Donau
 Visbek
Visbek
 Visselhovede
Visselhovede
 Vlotho
Vlotho
 Voerde
Voerde
 Vogelsdorf
Vogelsdorf
 Vohringen
Vohringen
 Volkach
Volkach
 Volklingen
Volklingen
 Vreden
Vreden
 Waakirchen
Waakirchen
 Wachtberg
Wachtberg
 Wachtendonk
Wachtendonk
 Wachtersbach
Wachtersbach
 Wadern
Wadern
 Wadgassen
Wadgassen
 Waghausel
Waghausel
 Wahlstedt
Wahlstedt
 Waiblingen
Waiblingen
 Waldachtal
Waldachtal
 Waldaschaff
Waldaschaff
 Waldbrol
Waldbrol
 Waldbronn
Waldbronn
 Walddorfhaslach
Walddorfhaslach
 Waldeck
Waldeck
 Waldenbuch
Waldenbuch
 Waldenburg
Waldenburg
 Waldkirch
Waldkirch
 Waldkraiburg
Waldkraiburg
 Waldmohr
Waldmohr
 Waldmunchen
Waldmunchen
 Waldsee
Waldsee
 Waldshut-Tiengen
Waldshut-Tiengen
 Walheim
Walheim
 Walldorf
Walldorf
 Walldurn
Walldurn
 Wallenhorst
Wallenhorst
 Walluf
Walluf
 Walsrode
Walsrode
 Waltenhofen
Waltenhofen
 Waltersdorf
Waltersdorf
 Waltershausen
Waltershausen
 Walting
Walting
 Waltrop
Waltrop
 Walzbachtal
Walzbachtal
 Wandlitz
Wandlitz
 Wangen im Allgau
Wangen im Allgau
 Warburg
Warburg
 Wardenburg
Wardenburg
 Waren
Waren
 Warendorf
Warendorf
 Warstein
Warstein
 Wasserburg a.Inn
Wasserburg a.Inn
 Wedel
Wedel
 Wedemark
Wedemark
 Weener
Weener
 Weeze
Weeze
 Weferlingen
Weferlingen
 Wegberg
Wegberg
 Wehr
Wehr
 Wehrheim
Wehrheim
 Weiden
Weiden
 Weil am Rhein
Weil am Rhein
 Weil der Stadt
Weil der Stadt
 Weil im Schonbuch
Weil im Schonbuch
 Weilburg
Weilburg
 Weilerbach
Weilerbach
 Weilheim an der Teck
Weilheim an der Teck
 Weilheim in Oberbayern
Weilheim in Oberbayern
 Weimar
Weimar
 Weingarten
Weingarten
 Weinheim
Weinheim
 Weinsberg
Weinsberg
 Weinstadt
Weinstadt
 Weisenheim am Sand
Weisenheim am Sand
 Weismain
Weismain
 Weissach
Weissach
 Weissenbrunn
Weissenbrunn
 Weissenburg in Bayern
Weissenburg in Bayern
 Weissenfels
Weissenfels
 Weissenhorn
Weissenhorn
 Weissensee
Weissensee
 Weisswasser
Weisswasser
 Weiterstadt
Weiterstadt
 Weitnau
Weitnau
 Welzheim
Welzheim
 Wendelstein
Wendelstein
 Wenden
Wenden
 Wendlingen
Wendlingen
 Wentorf bei Hamburg
Wentorf bei Hamburg
 Werdau
Werdau
 Werder
Werder
 Werdohl
Werdohl
 Werl
Werl
 Werlte
Werlte
 Wermelskirchen
Wermelskirchen
 Wernberg-Koblitz
Wernberg-Koblitz
 Werne
Werne
 Werneck
Werneck
 Wernigerode
Wernigerode
 Wertheim am Main
Wertheim am Main
 Wertingen
Wertingen
 Wesel
Wesel
 Wesseling
Wesseling
 Wessling
Wessling
 Westerburg
Westerburg
 Westerland
Westerland
 Westerstede
Westerstede
 Westhausen
Westhausen
 Westoverledingen
Westoverledingen
 Wetter
Wetter
 Wetzlar
Wetzlar
 Wiefelstede
Wiefelstede
 Wiehl
Wiehl
 Wiernsheim
Wiernsheim
 Wiesbaden
Wiesbaden
 Wiesloch
Wiesloch
 Wiesmoor
Wiesmoor
 Wietmarschen
Wietmarschen
 Wietze
Wietze
 Wiggensbach
Wiggensbach
 Wildau
Wildau
 Wildberg
Wildberg
 Wildeshausen
Wildeshausen
 Wilhelmshaven
Wilhelmshaven
 Wilhelmsthal
Wilhelmsthal
 Willich
Willich
 Willingen (Upland)
Willingen (Upland)
 Willstatt
Willstatt
 Wilnsdorf
Wilnsdorf
 Windeck
Windeck
 Winnenden
Winnenden
 Winsen
Winsen
 Winsen an der Aller
Winsen an der Aller
 Winterberg
Winterberg
 Wipperfurth
Wipperfurth
 Wismar
Wismar
 Wissen
Wissen
 Witten
Witten
 Wittenberg
Wittenberg
 Wittenberge
Wittenberge
 Wittlich-Land
Wittlich-Land
 Wittmund
Wittmund
 Wittstock
Wittstock
 Wolfenbuttel
Wolfenbuttel
 Wolfertschwenden
Wolfertschwenden
 Wolfhagen
Wolfhagen
 Wolfratshausen
Wolfratshausen
 Wolfsburg
Wolfsburg
 Wolfstein
Wolfstein
 Wolgast
Wolgast
 Wolnzach
Wolnzach
 Worms
Worms
 Worpswede
Worpswede
 Worrstadt
Worrstadt
 Worth am Rhein
Worth am Rhein
 Wulfrath
Wulfrath
 Wunsdorf
Wunsdorf
 Wunstorf
Wunstorf
 Wuppertal
Wuppertal
 Wurselen
Wurselen
 Wurzburg
Wurzburg
 Wurzen
Wurzen
 Wusterhausen
Wusterhausen
 Wustermark
Wustermark
 Xanten
Xanten
 Zabeltitz
Zabeltitz
 Zaberfeld
Zaberfeld
 Zandt
Zandt
 Zehnhausen bei Rennerod
Zehnhausen bei Rennerod
 Zeitz
Zeitz
 Zell
Zell
 Zell im Wiesental
Zell im Wiesental
 Zell unter Aichelberg
Zell unter Aichelberg
 Zeulenroda-Triebes
Zeulenroda-Triebes
 Zeuthen
Zeuthen
 Zeven
Zeven
 Zinnowitz
Zinnowitz
 Zirndorf
Zirndorf
 Zittau
Zittau
 Zossen
Zossen
 Zulpich
Zulpich
 Zweibrucken
Zweibrucken
 Zwickau
Zwickau
 Zwiesel
Zwiesel
 Zwonitz
Zwonitz
✗ Close categories
✗ Close categories
✗ Close categories
 Aaliyah
Aaliyah
 Abdullah Öcalan
Abdullah Öcalan
 Abdullah II Konig von Jordanien
Abdullah II Konig von Jordanien
 Abdullah König von Saudi-Arabien
Abdullah König von Saudi-Arabien
 Adele
Adele
 Ahmet Arslan
Ahmet Arslan
 Ai Weiwei
Ai Weiwei
 Akihito Kaiser von Japan
Akihito Kaiser von Japan
 Albert Fürst von Monaco
Albert Fürst von Monaco
 Albert II Konig von Belgien
Albert II Konig von Belgien
 Alexander Baumjohann
Alexander Baumjohann
 Alexej Iwanowitsch Adschubej
Alexej Iwanowitsch Adschubej
 Alfred Andersch
Alfred Andersch
 Amal Alamuddin Clooney
Amal Alamuddin Clooney
 André Ramalho
André Ramalho
 Andre Agassi
Andre Agassi
 Andrea Sawatzki
Andrea Sawatzki
 Andrea Vosshoff
Andrea Vosshoff
 Andrew Herzog von York
Andrew Herzog von York
 Andrzej Duda
Andrzej Duda
 Ang Lee
Ang Lee
 Angela Merkel
Angela Merkel
 Angriffe von Hunden
Angriffe von Hunden
 Anne Prinzessin von Grossbritannien
Anne Prinzessin von Grossbritannien
 Anne Will Talkshow
Anne Will Talkshow
 Antje Moldner-Schmidt
Antje Moldner-Schmidt
 Anton Hofreiter
Anton Hofreiter
 Anwar al-Awlaki
Anwar al-Awlaki
 Arthur Abraham
Arthur Abraham
 Arturo Vidal
Arturo Vidal
 Änis Ben-Hatira
Änis Ben-Hatira
 Bamba Anderson
Bamba Anderson
 Baschar al-Assad
Baschar al-Assad
 Batuhan Altıntaş
Batuhan Altıntaş
 Bela Anda
Bela Anda
 Bertie Ahern
Bertie Ahern
 Carlos Ascues
Carlos Ascues
 Cecilia Attias
Cecilia Attias
 Charles Aránguiz
Charles Aránguiz
 Charlison Benschop
Charlison Benschop
 Christoph Ahlhaus
Christoph Ahlhaus
 Claudio Abbado
Claudio Abbado
 Damon Albarn
Damon Albarn
 Daniel Baier
Daniel Baier
 David Abraham
David Abraham
 David Alaba
David Alaba
 Dennis Aogo
Dennis Aogo
 Diego Benaglio
Diego Benaglio
 Douglas Adams
Douglas Adams
 Emil Balayev
Emil Balayev
 Ermin Bičakčić
Ermin Bičakčić
 Ernst Albrecht
Ernst Albrecht
 Fatih Akin
Fatih Akin
 Ferran Adria
Ferran Adria
 Fin Bartels
Fin Bartels
 Fleetwood Mac
Fleetwood Mac
 Florida Georgia Line
Florida Georgia Line
 Foo Fighters
Foo Fighters
 Frank Asbeck
Frank Asbeck
 Franz-Josef Antwerpes
Franz-Josef Antwerpes
 Galib Andang
Galib Andang
 Gareth Bale
Gareth Bale
 Garth Brooks
Garth Brooks
 Gerald Asamoah
Gerald Asamoah
 Gerd Andres
Gerd Andres
 Gerry Adams
Gerry Adams
 Gianni Agnelli
Gianni Agnelli
 Gilbert Arenas
Gilbert Arenas
 Gisele Bündchen
Gisele Bündchen
 Giulio Andreotti
Giulio Andreotti
 Gloria Macapagal Arroyo
Gloria Macapagal Arroyo
 Gordon Ramsay
Gordon Ramsay
 Hafis al-Assad
Hafis al-Assad
 Halil Altintop
Halil Altintop
 Hannah Arendt
Hannah Arendt
 Hans Apel
Hans Apel
 Hans Arp
Hans Arp
 Hans Herbert von Arnim
Hans Herbert von Arnim
 Heinrich Albertz
Heinrich Albertz
 Heinz Ludwig Arnold
Heinz Ludwig Arnold
 Hermann Josef Abs
Hermann Josef Abs
 Hermann Josef Arentz
Hermann Josef Arentz
 Herzogin von Alba
Herzogin von Alba
 Holger Apfel
Holger Apfel
 Holger Badstuber
Holger Badstuber
 Howard Stern
Howard Stern
 Ibrahim Anwar
Ibrahim Anwar
 Isabelle Adjani
Isabelle Adjani
 Ismail Azzaoui
Ismail Azzaoui
 Jack Abramoff
Jack Abramoff
 Jackie Chan
Jackie Chan
 Jacques Attali
Jacques Attali
 Jakob Arjouni
Jakob Arjouni
 James Patterson
James Patterson
 James Rodriguez
James Rodriguez
 Jane Austen
Jane Austen
 Janne Ahonen
Janne Ahonen
 Jason Aldean
Jason Aldean
 Jay Z
Jay Z
 Jörg Asmussen
Jörg Asmussen
 Jean Asselborn
Jean Asselborn
 Jean-Bertrand Aristide
Jean-Bertrand Aristide
 Jean-Jacques Annaud
Jean-Jacques Annaud
 Jennifer Aniston
Jennifer Aniston
 Jennifer Lawrence
Jennifer Lawrence
 Jennifer Lopez
Jennifer Lopez
 Jerry Seinfeld
Jerry Seinfeld
 Jessica Alba
Jessica Alba
 Jim Parsons
Jim Parsons
 Jimmy Buffett
Jimmy Buffett
 John Abizaid
John Abizaid
 Johnny Depp
Johnny Depp
 Jon Lester
Jon Lester
 Jose Maria Aznar
Jose Maria Aznar
 Judy Sheindlin
Judy Sheindlin
 Julian Assange
Julian Assange
 Julian Baumgartlinger
Julian Baumgartlinger
 Jurij Andropow
Jurij Andropow
 Justin Timberlake
Justin Timberlake
 Kaan Ayhan
Kaan Ayhan
 Kaley Cuoco-Sweeting
Kaley Cuoco-Sweeting
 Karim Aga Khan
Karim Aga Khan
 Karim Bellarabi
Karim Bellarabi
 Karl Albrecht
Karl Albrecht
 Karl Angerer
Karl Angerer
 Katy Perry
Katy Perry
 Kenny Chesney
Kenny Chesney
 Kevin Durant
Kevin Durant
 Kevin Hart
Kevin Hart
 Kim Kardashian
Kim Kardashian
 Kobe Bryant
Kobe Bryant
 Kofi Annan
Kofi Annan
 Konrad Adenauer
Konrad Adenauer
 Kweku Adoboli
Kweku Adoboli
 Lady Gaga
Lady Gaga
 Lale Andersen
Lale Andersen
 Lance Armstrong
Lance Armstrong
 Lars Bender
Lars Bender
 LeBron James
LeBron James
 Leon Andreasen
Leon Andreasen
 Leon Balogun
Leon Balogun
 Leonardo Bittencourt
Leonardo Bittencourt
 Leonardo DiCaprio
Leonardo DiCaprio
 Levent Aycicek
Levent Aycicek
 Lewis Hamilton
Lewis Hamilton
 Lionel Messi
Lionel Messi
 Louis Aragon
Louis Aragon
 Louis Armstrong
Louis Armstrong
 Luiz Adriano
Luiz Adriano
 Luke Bryan
Luke Bryan
 Madeleine Albright
Madeleine Albright
 Mahendra Singh Dhoni
Mahendra Singh Dhoni
 Maher Arar
Maher Arar
 Mahmoud Abbas
Mahmoud Abbas
 Mahmud Ahmadinedschad
Mahmud Ahmadinedschad
 Manfred von Ardenne
Manfred von Ardenne
 Manny Pacquiao
Manny Pacquiao
 Mansur Adli
Mansur Adli
 Marc Andreessen
Marc Andreessen
 Marc Anthony
Marc Anthony
 Maria Sharapova
Maria Sharapova
 Marina Abramovic
Marina Abramovic
 Mario Adorf
Mario Adorf
 Mark Wahlberg
Mark Wahlberg
 Maroon 5
Maroon 5
 Martha Argerich
Martha Argerich
 Martine Aubry
Martine Aubry
 Martti Ahtisaari
Martti Ahtisaari
 Max Kruse
Max Kruse
 Maximilian Arnold
Maximilian Arnold
 Maximilian Beister
Maximilian Beister
 Medhi Benatia
Medhi Benatia
 Mehmet Ali Agca
Mehmet Ali Agca
 Michael Bublé
Michael Bublé
 Michelangelo Antonioni
Michelangelo Antonioni
 Miiko Albornoz
Miiko Albornoz
 Mike-Steven Bähre
Mike-Steven Bähre
 Miranda Lambert
Miranda Lambert
 Muhlis Mehmet Ari
Muhlis Mehmet Ari
 Nadiem Amiri
Nadiem Amiri
 Nadine Angerer
Nadine Angerer
 Nadja Auermann
Nadja Auermann
 Ndamukong Suh
Ndamukong Suh
 Neil Armstrong
Neil Armstrong
 Neymar
Neymar
 Nicklas Bendtner
Nicklas Bendtner
 Niels Annen
Niels Annen
 Novak Djokovic
Novak Djokovic
 Oliver Baumann
Oliver Baumann
 One Direction
One Direction
 Otto Addo
Otto Addo
 Pamela Anderson
Pamela Anderson
 Patricio Aylwin
Patricio Aylwin
 Paul Auster
Paul Auster
 Paul McCartney
Paul McCartney
 Paul Thomas Anderson
Paul Thomas Anderson
 Pharrell Williams
Pharrell Williams
 Phil Mickelson
Phil Mickelson
 Philipp Bargfrede
Philipp Bargfrede
 Pierre Bengtsson
Pierre Bengtsson
 Pierre-Emerick Aubameyang
Pierre-Emerick Aubameyang
 Rafael Nadal
Rafael Nadal
 René Adler
René Adler
 Richard Attenborough
Richard Attenborough
 Richard Avedon
Richard Avedon
 Roald Amundsen
Roald Amundsen
 Robert Bauer
Robert Bauer
 Robert Downey Jr.
Robert Downey Jr.
 Robin Becker
Robin Becker
 Roger Federer
Roger Federer
 Rolling Stones
Rolling Stones
 Roman Abramowitsch
Roman Abramowitsch
 Ron Arad
Ron Arad
 Rory McIlroy
Rory McIlroy
 Roy Beerens
Roy Beerens
 Rudi Assauer
Rudi Assauer
 Rudolf Augstein
Rudolf Augstein
 Rush Limbaugh
Rush Limbaugh
 Ryan Seacrest
Ryan Seacrest
 Salman Khan
Salman Khan
 Sami Allagui
Sami Allagui
 Sani Abacha
Sani Abacha
 Sarah Ferguson
Sarah Ferguson
 Sascha Anderson
Sascha Anderson
 Saud ibn Abd al-Aziz
Saud ibn Abd al-Aziz
 Scarlett Johansson
Scarlett Johansson
 Sean Combs
Sean Combs
 Sean Hannity
Sean Hannity
 Sebastian Vettel
Sebastian Vettel
 Shinzo Abe
Shinzo Abe
 Sofía Vergara
Sofía Vergara
 Souhaila Andrawes
Souhaila Andrawes
 Stefan Aigner
Stefan Aigner
 Stefan Aust
Stefan Aust
 Stefan Bell
Stefan Bell
 Susanne Albrecht
Susanne Albrecht
 Sven Bender
Sven Bender
 Tariq Aziz
Tariq Aziz
 Taylor Swift
Taylor Swift
 The Eagles
The Eagles
 Theo Albrecht
Theo Albrecht
 Theo Angelopoulos
Theo Angelopoulos
 Thomas Anders
Thomas Anders
 Tiesto
Tiesto
 Tiger Woods
Tiger Woods
 Tim McGraw
Tim McGraw
 Timo Baumgartl
Timo Baumgartl
 Tobias Angerer
Tobias Angerer
 Toby Keith
Toby Keith
 Tom Cruise
Tom Cruise
 Tony Abbott
Tony Abbott
 Torsten Albig
Torsten Albig
 Uffe Bech
Uffe Bech
 Umberto Agnelli
Umberto Agnelli
 Uri Avnery
Uri Avnery
 Vin Diesel
Vin Diesel
 Viswanathan Anand
Viswanathan Anand
 Waldemar Anton
Waldemar Anton
 Zac Brown Band
Zac Brown Band
 Zlatan Ibrahimovic
Zlatan Ibrahimovic
✗ Close categories
✗ Close categories
✗ Close categories
 Gefahrenabwehr
Gefahrenabwehr
 Administrativ
Administrativ
 Analysten
Analysten
 Antiquitatenhandel
Antiquitatenhandel
 Apotheker
Apotheker
 Archäologie
Archäologie
 Architektur
Architektur
 Arzte
Arzte
 Astrologie
Astrologie
 Automobilindustrie
Automobilindustrie
 Banken
Banken
 Bau
Bau
 Bauwerk
Bauwerk
 Bauwesen
Bauwesen
 Bäckerei
Bäckerei
 Beratung
Beratung
 Berufseinsteiger
Berufseinsteiger
 Berufskraftfahrer
Berufskraftfahrer
 Betreuung
Betreuung
 Bibliothek
Bibliothek
 Biologie
Biologie
 Blumen
Blumen
 Buchhaltung
Buchhaltung
 Call-center
Call-center
 Chemie
Chemie
 Coaching
Coaching
 Computer
Computer
 Dj
Dj
 DV
DV
 Einzelhandel
Einzelhandel
 Elektro
Elektro
 Energiewirtschaft
Energiewirtschaft
 Feuerwehr
Feuerwehr
 Finanzberatung
Finanzberatung
 Finanzen
Finanzen
 FMCG
FMCG
 Friseur
Friseur
 Gastgewerbe
Gastgewerbe
 Gastronomie
Gastronomie
 Genealogie
Genealogie
 HR Manager
HR Manager
 Immobilien
Immobilien
 Ingenieurwesen
Ingenieurwesen
 IT
IT
 Krankenschwester
Krankenschwester
 Kundenmanagement
Kundenmanagement
 Landwirtschaftliche Bereich
Landwirtschaftliche Bereich
 Logistik
Logistik
 Management
Management
 Marketing
Marketing
 Mathematik
Mathematik
 Mechatroniker
Mechatroniker
 Medizin
Medizin
 Mode
Mode
 Molkereiindustrie
Molkereiindustrie
 Online Marketing
Online Marketing
 Personal
Personal
 Pharmazie
Pharmazie
 Physik
Physik
 Physiotherapeut
Physiotherapeut
 Polizei
Polizei
 Public Relations
Public Relations
 Rechtsanwaltschaft
Rechtsanwaltschaft
 Servicekraft
Servicekraft
 Social Media beratung
Social Media beratung
 Stahlindustrie
Stahlindustrie
 Teilzeit
Teilzeit
 Tourismos
Tourismos
 Unternehmer
Unternehmer
 Verkaufer
Verkaufer
 Vermessung
Vermessung
 Versicherungen
Versicherungen
 Vertrieb
Vertrieb
 Verwaltung
Verwaltung
 Werbung
Werbung
 Wirtschaft
Wirtschaft
 Wohltätigkeitsorganisationen
Wohltätigkeitsorganisationen
 Zahnarzt
Zahnarzt
✗ Close categories
✗ Close categories
✗ Close categories
 $ABBC ABBC Coin
$ABBC ABBC Coin
 $ABT Arcblock
$ABT Arcblock
 $ADA Cardano
$ADA Cardano
 $ADK Aidos Kuneen
$ADK Aidos Kuneen
 $AE Aeternity
$AE Aeternity
 $AGVC AgaveCoin
$AGVC AgaveCoin
 $AION Aion
$AION Aion
 $ALGO Algorand
$ALGO Algorand
 $ANT Aragon
$ANT Aragon
 $ARDR Ardor
$ARDR Ardor
 $ARK Ark
$ARK Ark
 $ATOM Cosmos
$ATOM Cosmos
 $BASE Base Protocol
$BASE Base Protocol
 $BAT Basic Attention Token
$BAT Basic Attention Token
 $BCD Bitcoin Diamond
$BCD Bitcoin Diamond
 $BCH Bitcoin Cash
$BCH Bitcoin Cash
 $BCN Bytecoin
$BCN Bytecoin
 $BCZERO Buggyra Coin Zero
$BCZERO Buggyra Coin Zero
 $BDX Beldex
$BDX Beldex
 $BEAM Beam
$BEAM Beam
 $BF BitForex Token
$BF BitForex Token
 $BHD BitcoinHD
$BHD BitcoinHD
 $BHP BHPCoin
$BHP BHPCoin
 $BIX Bibox Token
$BIX Bibox Token
 $BLOCK Blocknet
$BLOCK Blocknet
 $BNB Binance Coin
$BNB Binance Coin
 $BNK Bankera
$BNK Bankera
 $BNT Bancor
$BNT Bancor
 $BOA BOSAGORA
$BOA BOSAGORA
 $BONDLY Bondly
$BONDLY Bondly
 $BOTX botXcoin
$BOTX botXcoin
 $BRD Bread
$BRD Bread
 $BRZE Breezecoin
$BRZE Breezecoin
 $BST BlockStamp
$BST BlockStamp
 $BSV Bitcoin SV
$BSV Bitcoin SV
 $BTC Bitcoin
$BTC Bitcoin
 $BTC2 Bitcoin 2
$BTC2 Bitcoin 2
 $BTG Bitcoin Gold
$BTG Bitcoin Gold
 $BTM Bytom
$BTM Bytom
 $BTMX BitMax Token
$BTMX BitMax Token
 $BTS BitShares
$BTS BitShares
 $BTT BitTorrent
$BTT BitTorrent
 $BUSD Binance USD
$BUSD Binance USD
 $BXK Bitbook Gambling
$BXK Bitbook Gambling
 $CCA Counos Coin
$CCA Counos Coin
 $CENNZ Centrality
$CENNZ Centrality
 $CHSB SwissBorg
$CHSB SwissBorg
 $CHZ Chiliz
$CHZ Chiliz
 $CIX100 Cryptoindex.com 100
$CIX100 Cryptoindex.com 100
 $CKB Nervos Network
$CKB Nervos Network
 $CNX Cryptonex
$CNX Cryptonex
 $CRO Crypto.com Coin
$CRO Crypto.com Coin
 $CRPT Crypterium
$CRPT Crypterium
 $CSC CasinoCoin
$CSC CasinoCoin
 $CTXC Cortex
$CTXC Cortex
 $CVC Civic
$CVC Civic
 $DAG Constellation
$DAG Constellation
 $DAI Multi-collateral DAI
$DAI Multi-collateral DAI
 $DASH Dash
$DASH Dash
 $DCN Dentacoin
$DCN Dentacoin
 $DCR Decred
$DCR Decred
 $DDIM DuckDAO Dime
$DDIM DuckDAO Dime
 $DENT Dent
$DENT Dent
 $DGB DigiByte
$DGB DigiByte
 $DGD DigixDAO
$DGD DigixDAO
 $DGTX Digitex Futures
$DGTX Digitex Futures
 $DIVI Divi
$DIVI Divi
 $DMT DMarket
$DMT DMarket
 $DOGE Dogecoin
$DOGE Dogecoin
 $DPT Diamond Platform Token
$DPT Diamond Platform Token
 $DRG Dragon Coins
$DRG Dragon Coins
 $DTR Dynamic Trading Rights
$DTR Dynamic Trading Rights
 $DUCK Duck Liquidity Pool
$DUCK Duck Liquidity Pool
 $DX DxChain Token
$DX DxChain Token
 $ECOREAL Ecoreal Estate
$ECOREAL Ecoreal Estate
 $EDC EDC Blockchain
$EDC EDC Blockchain
 $EKT EDUCare
$EKT EDUCare
 $ELA Elastos
$ELA Elastos
 $ELF aelf
$ELF aelf
 $ENG Enigma
$ENG Enigma
 $ENJ Enjin Coin
$ENJ Enjin Coin
 $EON Dimension Chain
$EON Dimension Chain
 $EOS EOS
$EOS EOS
 $ERD Elrond
$ERD Elrond
 $ETC Ethereum Classic
$ETC Ethereum Classic
 $ETH Ethereum
$ETH Ethereum
 $ETN Electroneum
$ETN Electroneum
 $ETP Metaverse ETP
$ETP Metaverse ETP
 $EURS STASIS EURO
$EURS STASIS EURO
 $EVR Everus
$EVR Everus
 $FAB FABRK
$FAB FABRK
 $FCT Factom
$FCT Factom
 $FET Fetch.ai
$FET Fetch.ai
 $FLG Folgory Coin
$FLG Folgory Coin
 $FST 1irstcoin
$FST 1irstcoin
 $FTM Fantom
$FTM Fantom
 $FTT FTX Token
$FTT FTX Token
 $FUN FunFair
$FUN FunFair
 $FXC Flexacoin
$FXC Flexacoin
 $GAP GAPS
$GAP GAPS
 $GNO Gnosis
$GNO Gnosis
 $GNT Golem
$GNT Golem
 $GO GoChain
$GO GoChain
 $GRIN Grin
$GRIN Grin
 $GRS Groestlcoin
$GRS Groestlcoin
 $GT Gatechain Token
$GT Gatechain Token
 $GTN GlitzKoin
$GTN GlitzKoin
 $GXC GXChain
$GXC GXChain
 $HBAR Hedera Hashgraph
$HBAR Hedera Hashgraph
 $HC HyperCash
$HC HyperCash
 $HEDG HedgeTrade
$HEDG HedgeTrade
 $HOT Holo
$HOT Holo
 $HPT Huobi Pool Token
$HPT Huobi Pool Token
 $HT Huobi Token
$HT Huobi Token
 $HYN Hyperion
$HYN Hyperion
 $ICX ICON
$ICX ICON
 $IGNIS Ignis
$IGNIS Ignis
 $ILC ILCoin
$ILC ILCoin
 $INB Insight Chain
$INB Insight Chain
 $INO INO COIN
$INO INO COIN
 $IOST IOST
$IOST IOST
 $IOTX IoTeX
$IOTX IoTeX
 $JUL Joule
$JUL Joule
 $KAN BitKan
$KAN BitKan
 $KBC Karatgold Coin
$KBC Karatgold Coin
 $KCS KuCoin Shares
$KCS KuCoin Shares
 $KICK KickToken
$KICK KickToken
 $KMD Komodo
$KMD Komodo
 $KNC Kyber Network
$KNC Kyber Network
 $LA LATOKEN
$LA LATOKEN
 $LAMB Lambda
$LAMB Lambda
 $LBA Cred
$LBA Cred
 $LEND Aave
$LEND Aave
 $LEO UNUS SED LEO
$LEO UNUS SED LEO
 $LINA Linear Finance
$LINA Linear Finance
 $LINK Chainlink
$LINK Chainlink
 $LOKI Loki
$LOKI Loki
 $LOOM Loom Network
$LOOM Loom Network
 $LRC Loopring
$LRC Loopring
 $LSK Lisk
$LSK Lisk
 $LTC Litecoin
$LTC Litecoin
 $LUNA Terra
$LUNA Terra
 $MAID MaidSafeCoin
$MAID MaidSafeCoin
 $MANA Decentraland
$MANA Decentraland
 $MATIC Matic Network
$MATIC Matic Network
 $MB MineBee
$MB MineBee
 $MCO MCO
$MCO MCO
 $MDA Moeda Loyalty Points
$MDA Moeda Loyalty Points
 $MIN MINDOL
$MIN MINDOL
 $MIOTA IOTA
$MIOTA IOTA
 $MKR Maker
$MKR Maker
 $MOF Molecular Future
$MOF Molecular Future
 $MONA MonaCoin
$MONA MonaCoin
 $MTL Metal
$MTL Metal
 $MX MX Token
$MX MX Token
 $NANO Nano
$NANO Nano
 $NAS Nebulas
$NAS Nebulas
 $NEO Neo
$NEO Neo
 $NET NEXT
$NET NEXT
 $NEW Newton
$NEW Newton
 $NEX Nash Exchange
$NEX Nash Exchange
 $NEXO Nexo
$NEXO Nexo
 $NMR Numeraire
$NMR Numeraire
 $NOAH Noah Coin
$NOAH Noah Coin
 $NPXS Pundi X
$NPXS Pundi X
 $NRG Energi
$NRG Energi
 $NULS NULS
$NULS NULS
 $NXT Nxt
$NXT Nxt
 $OCEAN Ocean Protocol
$OCEAN Ocean Protocol
 $OKB OKB
$OKB OKB
 $OMG OmiseGO
$OMG OmiseGO
 $ONE BigONE Token
$ONE BigONE Token
 $ONE Harmony
$ONE Harmony
 $ONT Ontology
$ONT Ontology
 $PAI Project Pai
$PAI Project Pai
 $PAX Paxos Standard
$PAX Paxos Standard
 $PIVX PIVX
$PIVX PIVX
 $PLC PLATINCOIN
$PLC PLATINCOIN
 $POOLZ Poolz
$POOLZ Poolz
 $POWR Power Ledger
$POWR Power Ledger
 $PPAY PlasmaPay
$PPAY PlasmaPay
 $PPT Populous
$PPT Populous
 $PZM PRIZM
$PZM PRIZM
 $QASH QASH
$QASH QASH
 $QBIT Qubitica
$QBIT Qubitica
 $QC QCash
$QC QCash
 $QNT Quant
$QNT Quant
 $QTUM Qtum
$QTUM Qtum
 $R Revain
$R Revain
 $RCN Ripio Credit Network
$RCN Ripio Credit Network
 $RDD ReddCoin
$RDD ReddCoin
 $REN Ren
$REN Ren
 $REP Augur
$REP Augur
 $RIF RIF Token
$RIF RIF Token
 $RLC iExec RLC
$RLC iExec RLC
 $ROX Robotina
$ROX Robotina
 $RUNE THORChain
$RUNE THORChain
 $RVN Ravencoin
$RVN Ravencoin
 $SAI Single Collateral DAI
$SAI Single Collateral DAI
 $SC Siacoin
$SC Siacoin
 $SEELE Seele
$SEELE Seele
 $SNT Status
$SNT Status
 $SNX Synthetix Network Token
$SNX Synthetix Network Token
 $SOLVE SOLVE
$SOLVE SOLVE
 $STEEM Steem
$STEEM Steem
 $STORJ Storj
$STORJ Storj
 $STRAT Stratis
$STRAT Stratis
 $STREAM Streamit Coin
$STREAM Streamit Coin
 $STX Blockstack
$STX Blockstack
 $SXP Swipe
$SXP Swipe
 $SYS Syscoin
$SYS Syscoin
 $TAGZ5 TAGZ5
$TAGZ5 TAGZ5
 $THETA THETA
$THETA THETA
 $THR ThoreCoin
$THR ThoreCoin
 $THX ThoreNext
$THX ThoreNext
 $TNT Tierion
$TNT Tierion
 $TOMO TomoChain
$TOMO TomoChain
 $TRAT Tratin
$TRAT Tratin
 $TRUE TrueChain
$TRUE TrueChain
 $TRX TRON
$TRX TRON
 $TT Thunder Token
$TT Thunder Token
 $TUSD TrueUSD
$TUSD TrueUSD
 $UBT Unibright
$UBT Unibright
 $USDC USD Coin
$USDC USD Coin
 $USDK USDK
$USDK USDK
 $USDT Tether
$USDT Tether
 $VEST VestChain
$VEST VestChain
 $VET VeChain
$VET VeChain
 $VITAE Vitae
$VITAE Vitae
 $VLX Velas
$VLX Velas
 $VSYS V Systems
$VSYS V Systems
 $VTC Vertcoin
$VTC Vertcoin
 $WAN Wanchain
$WAN Wanchain
 $WAVES Waves
$WAVES Waves
 $WAXP WAX
$WAXP WAX
 $WICC WaykiChain
$WICC WaykiChain
 $WIN WINk
$WIN WINk
 $WTC Waltonchain
$WTC Waltonchain
 $WXT Wirex Token
$WXT Wirex Token
 $XEM NEM
$XEM NEM
 $XET ETERNAL TOKEN
$XET ETERNAL TOKEN
 $XIN Mixin
$XIN Mixin
 $XLM Stellar
$XLM Stellar
 $XMR Monero
$XMR Monero
 $XMX XMax
$XMX XMax
 $XRP XRP
$XRP XRP
 $XTP Tap
$XTP Tap
 $XTZ Tezos
$XTZ Tezos
 $XVG Verge
$XVG Verge
 $XZC Zcoin
$XZC Zcoin
 $YAP Yap Stone
$YAP Yap Stone
 $YOU YOU COIN
$YOU YOU COIN
 $ZB ZB Token
$ZB ZB Token
 $ZEC Zcash
$ZEC Zcash
 $ZEN Horizen
$ZEN Horizen
 $ZIL Zilliqa
$ZIL Zilliqa
 $ZRX 0x
$ZRX 0x
 Binance
Binance
 Bittrex
Bittrex
 HitBTC
HitBTC
 Huobi
Huobi
 Kraken
Kraken
 Kucoin
Kucoin
✗ Close categories
✗ Close categories
-
Polio: Pathogene Impfstoffviren in mehreren europäischen Ländern stammen vermutlich aus Afrika
 Kopenhagen – Die Herkunft der aus dem oralen Impfstoff entstandenen pathogenen Polioviren, die in den letzten Wochen und Monaten in Spanien, Polen, Finnland, Großbritannien und Deutschland in Abwässern nachgewiesen wurden, konnte bisher nicht genau geklärt werden. Wie... [weiter lesen]
Kopenhagen – Die Herkunft der aus dem oralen Impfstoff entstandenen pathogenen Polioviren, die in den letzten Wochen und Monaten in Spanien, Polen, Finnland, Großbritannien und Deutschland in Abwässern nachgewiesen wurden, konnte bisher nicht genau geklärt werden. Wie... [weiter lesen] -
Italiens Flüchtlingspolitik: Ärzte ohne Grenzen stellt Rettung von Migranten ein
 Rom – Die Hilfsorganisation Ärzte ohne Grenzen stellt ihre Rettungseinsätze für Migranten im zentralen Mittelmeer ein. Grund sei, dass die „Gesetze und die Politik Italiens“ die Weiterführung des derzeitigen Modells „unmöglich machen“, erklärte die Organisation heute. Das... [weiter lesen]
Rom – Die Hilfsorganisation Ärzte ohne Grenzen stellt ihre Rettungseinsätze für Migranten im zentralen Mittelmeer ein. Grund sei, dass die „Gesetze und die Politik Italiens“ die Weiterführung des derzeitigen Modells „unmöglich machen“, erklärte die Organisation heute. Das... [weiter lesen] -
Thüringen: Frisch ernannte Gesundheitsministerin Schenk wird in wenigen Tagen Vorsitzende der GMK
 Berlin/Erfurt – Die gerade ernannte Gesundheitsministerin in Thüringen, Katharina Schenk (SPD), wird zu Jahresbeginn auch Vorsitzende der Gesundheitsministerkonferenz (GMK) werden. Thüringen hat turnusgemäß 2025 den Vorsitz der Konferenz der Landesgesundheitsministerinnen... [weiter lesen]
Berlin/Erfurt – Die gerade ernannte Gesundheitsministerin in Thüringen, Katharina Schenk (SPD), wird zu Jahresbeginn auch Vorsitzende der Gesundheitsministerkonferenz (GMK) werden. Thüringen hat turnusgemäß 2025 den Vorsitz der Konferenz der Landesgesundheitsministerinnen... [weiter lesen] -
Gesetzliche Kassen warnen vor noch stärker steigenden Beiträgen als erwartet
 Berlin – Der Spitzenverband der Gesetzlichen Krankenversicherung (GKV-Spitzenverband) warnt vor stärker steigenden Kassenbeiträgen zum Jahreswechsel als erwartet. Der von jeder einzelnen Kasse berechnete Zusatzbeitrag drohe in vielen Fällen den von der Bundesregierung... [weiter lesen]
Berlin – Der Spitzenverband der Gesetzlichen Krankenversicherung (GKV-Spitzenverband) warnt vor stärker steigenden Kassenbeiträgen zum Jahreswechsel als erwartet. Der von jeder einzelnen Kasse berechnete Zusatzbeitrag drohe in vielen Fällen den von der Bundesregierung... [weiter lesen] -
Konsum von hochverarbeiteten Lebensmitteln mit Psoriasis assoziiert
 Créteil – Ein hoher Konsum hochverarbeiteter Lebensmitteln geht mit einem erhöhten Risiko für eine aktive Psoriasis einher. Das zeigt eine Querschnittstudie aus Frankreich, über deren Ergebnisse Forschende jetzt in JAMA Dermatology berichten (2024; DOI:... [weiter lesen]
Créteil – Ein hoher Konsum hochverarbeiteter Lebensmitteln geht mit einem erhöhten Risiko für eine aktive Psoriasis einher. Das zeigt eine Querschnittstudie aus Frankreich, über deren Ergebnisse Forschende jetzt in JAMA Dermatology berichten (2024; DOI:... [weiter lesen] -
Personalisiertes Blutbild könnte Diagnose von Krankheiten erleichtern
 Boston – Das Blutbild gesunder Menschen ist genetisch festgelegt und die einzelnen Komponenten verändern sich im Verlauf von Jahrzehnten kaum. Dies zeigt eine Analyse der elektronischen Krankenakten von zehntausenden Patienten eines US-Klinikverbundes in Nature (2024, DOI:... [weiter lesen]
Boston – Das Blutbild gesunder Menschen ist genetisch festgelegt und die einzelnen Komponenten verändern sich im Verlauf von Jahrzehnten kaum. Dies zeigt eine Analyse der elektronischen Krankenakten von zehntausenden Patienten eines US-Klinikverbundes in Nature (2024, DOI:... [weiter lesen] -
Prophylaktischer Einsatz von Rifaximin bedroht Reserveantibiotikum Daptomycin
 Melbourne – Antibiotikaresistenzen entstehen manchmal auf unerwartetem Weg, wie die jetzt in Nature (2024; DOI: 10.1038/s41586-024-08095-4) veröffentlichten Ergebnisse einer australischen Arbeitsgruppe zeigen. Demnach sind die immer häufiger beobachteten Resistenzen gegen... [weiter lesen]
Melbourne – Antibiotikaresistenzen entstehen manchmal auf unerwartetem Weg, wie die jetzt in Nature (2024; DOI: 10.1038/s41586-024-08095-4) veröffentlichten Ergebnisse einer australischen Arbeitsgruppe zeigen. Demnach sind die immer häufiger beobachteten Resistenzen gegen... [weiter lesen] -
EU-Kommission startet Luftbrücke für Menschen in Syrien
 Brüssel – Die Europäische Kommission startet eine neue humanitäre Luftbrücke mit medizinischer Notversorgung und anderen lebenswichtigen Gütern für die Menschen in Syrien. Mit von der EU finanzierten Hilfsflügen sollen insgesamt 50 Tonnen medizinischer Hilfsgüter aus... [weiter lesen]
Brüssel – Die Europäische Kommission startet eine neue humanitäre Luftbrücke mit medizinischer Notversorgung und anderen lebenswichtigen Gütern für die Menschen in Syrien. Mit von der EU finanzierten Hilfsflügen sollen insgesamt 50 Tonnen medizinischer Hilfsgüter aus... [weiter lesen] -
Zerebralen Mikroangiopathie unterscheidet sich bei Frauen und Männern
 Graz – Die zerebrale Mikroangiopathie weist offenbar Unterschiede zwischen Frauen und Männern auf. Forschende aus Österreich berichten in JAMA Network Open (2024; DOI: 10.1001/jamanetworkopen.2024.39571) von Differenzen bei zerebralen Mikroblutungen, Veränderungen der... [weiter lesen]
Graz – Die zerebrale Mikroangiopathie weist offenbar Unterschiede zwischen Frauen und Männern auf. Forschende aus Österreich berichten in JAMA Network Open (2024; DOI: 10.1001/jamanetworkopen.2024.39571) von Differenzen bei zerebralen Mikroblutungen, Veränderungen der... [weiter lesen] -
Tumorwachstum findet nicht nur an der Grenzschicht statt
 Barcelona/Köln – Tumoren wachsen nicht nur an den äußeren Rändern, sondern gleichmäßig in ihrem gesamten Volumen. Das berichtet ein Forschungsteam der Universität zu Köln und des Centre for Genomic Regulation in Barcelona in der Fachzeitschrft eLIFE (2024; DOI:... [weiter lesen]
Barcelona/Köln – Tumoren wachsen nicht nur an den äußeren Rändern, sondern gleichmäßig in ihrem gesamten Volumen. Das berichtet ein Forschungsteam der Universität zu Köln und des Centre for Genomic Regulation in Barcelona in der Fachzeitschrft eLIFE (2024; DOI:... [weiter lesen] -
Hirnaneurysma: Bluttransfusionen können Behandlungsergebnisse von Subarachnoidalblutungen verbessern
 Ottawa/Kanada – Bluttransfusionen könnten bei Patienten mit akuten Subarachnoidalblutungen die Sauerstoffversorgung des Gehirns verbessern. Eine liberale Strategie, die Hb-Werte über 10 g/dl anstrebt, hat in einer randomisierten Studie im New England Journal of Medicine... [weiter lesen]
Ottawa/Kanada – Bluttransfusionen könnten bei Patienten mit akuten Subarachnoidalblutungen die Sauerstoffversorgung des Gehirns verbessern. Eine liberale Strategie, die Hb-Werte über 10 g/dl anstrebt, hat in einer randomisierten Studie im New England Journal of Medicine... [weiter lesen] -
Warnungen vor Versorgungslücken ohne syrische Fachkräfte
 Berlin – Ärzte- und Pflegevertreter warnen vor einer Versorgungslücke im Gesundheitswesen, sollten viele syrische Fachkräfte nach dem Umbruch in ihrem Herkunftsland Deutschland verlassen. „In ländlichen Regionen halten syrische Ärztinnen und Ärzte die Versorgung in... [weiter lesen]
Berlin – Ärzte- und Pflegevertreter warnen vor einer Versorgungslücke im Gesundheitswesen, sollten viele syrische Fachkräfte nach dem Umbruch in ihrem Herkunftsland Deutschland verlassen. „In ländlichen Regionen halten syrische Ärztinnen und Ärzte die Versorgung in... [weiter lesen] -
Slowakische Regierung droht Ärzten mit Arbeitspflicht und Gefängnis
 Berlin – Der Marburger Bund (MB) fordert die slowakische Regierung im Zusammenhang mit der Auseinandersetzung mit der Ärzteschaft auf, grundlegende Errungenschaften des europäischen Arbeitsrechts und der Grundrechtecharta nicht außer Kraft zu setzen. „Der Umgang der... [weiter lesen]
Berlin – Der Marburger Bund (MB) fordert die slowakische Regierung im Zusammenhang mit der Auseinandersetzung mit der Ärzteschaft auf, grundlegende Errungenschaften des europäischen Arbeitsrechts und der Grundrechtecharta nicht außer Kraft zu setzen. „Der Umgang der... [weiter lesen] -
Für Hälfte der Weltbevölkerung fehlen Ärzte
 Hannover – Der Hälfte der Weltbevölkerung fehlt es einer Studie zufolge an medizinischer Grundversorgung. Rund vier Milliarden Menschen hätten keinen stabilen Zugang zu medizinischen Fachkräften und entsprechender Infrastruktur, wie die Deutsche Stiftung Weltbevölkerung... [weiter lesen]
Hannover – Der Hälfte der Weltbevölkerung fehlt es einer Studie zufolge an medizinischer Grundversorgung. Rund vier Milliarden Menschen hätten keinen stabilen Zugang zu medizinischen Fachkräften und entsprechender Infrastruktur, wie die Deutsche Stiftung Weltbevölkerung... [weiter lesen] -
Etwas mehr als 20 Klinikinsolvenzen in diesem Jahr
 Berlin – In diesem Jahr mussten mindestens 24 Krankenhäuser Insolvenz anmelden. Einer Verbandsübersicht zufolge, die dem Deutschen Ärzteblatt vorliegt, sind seit Januar bis zum Stand 6. November 18 neue Insolvenzverfahren von Kliniken eröffnet worden. Davon sind drei... [weiter lesen]
Berlin – In diesem Jahr mussten mindestens 24 Krankenhäuser Insolvenz anmelden. Einer Verbandsübersicht zufolge, die dem Deutschen Ärzteblatt vorliegt, sind seit Januar bis zum Stand 6. November 18 neue Insolvenzverfahren von Kliniken eröffnet worden. Davon sind drei... [weiter lesen] -
Rheinland-Pfalz: Gutachten zur Krankenhausreform Anfang 2025 erwartet
 Mainz – Gesundheitsminister Clemens Hoch will bis Ende September 2025 weitgehende Klarheit über die Entwicklung der Krankenhauslandschaft in Rheinland-Pfalz haben. „Wir legen nächstes Jahr los, sobald ein in Auftrag gegebenes Gutachten da ist“, sagte der SPD-Politiker im... [weiter lesen]
Mainz – Gesundheitsminister Clemens Hoch will bis Ende September 2025 weitgehende Klarheit über die Entwicklung der Krankenhauslandschaft in Rheinland-Pfalz haben. „Wir legen nächstes Jahr los, sobald ein in Auftrag gegebenes Gutachten da ist“, sagte der SPD-Politiker im... [weiter lesen] -
Bundessozialgericht stärkt Eltern mit kranken und pflegebedürftigen Kindern
 Kassel – Ein krankheitsbedingt nicht mehr altersgerechter Aufwand für die Versorgung und Beaufsichtigung von Kindern kann zu einem höheren Pflegegeld führen. So sind Besonderheiten durch Diabetes, Spritzenangst und Mukoviszidose bei der Berechnung des Pflegegrads zu... [weiter lesen]
Kassel – Ein krankheitsbedingt nicht mehr altersgerechter Aufwand für die Versorgung und Beaufsichtigung von Kindern kann zu einem höheren Pflegegeld führen. So sind Besonderheiten durch Diabetes, Spritzenangst und Mukoviszidose bei der Berechnung des Pflegegrads zu... [weiter lesen] -
Teichert: Finanzierung von Hygienefachpersonen muss dauerhaft gesichert sein
 Berlin – Die Leiterin der Abteilung Öffentliche Gesundheit im Bundesgesundheitsministerium (BMG), Ute Teichert, hat sich dafür ausgesprochen, eine grundsätzliche Lösung für die Finanzierung von Hygienefachpersonen im deutschen Gesundheitswesen zu finden. „Wir müssen davon... [weiter lesen]
Berlin – Die Leiterin der Abteilung Öffentliche Gesundheit im Bundesgesundheitsministerium (BMG), Ute Teichert, hat sich dafür ausgesprochen, eine grundsätzliche Lösung für die Finanzierung von Hygienefachpersonen im deutschen Gesundheitswesen zu finden. „Wir müssen davon... [weiter lesen] -
Krankenhausgesellschaft Nordrhein-Westfalen: Nächste Bundesregierung muss Krankenhäuser stabilisieren
 Düsseldorf – Die kommende Bundesregierung müsse schnell nach Amtsantritt „die schweren Strickfehler der vom Bundestag ohne valide Kenntnis der Folgen verabschiedeten Krankenhausreform korrigieren“ und die Krankenhäuser stabilisieren. Dies forderte Ingo Morell, Präsident... [weiter lesen]
Düsseldorf – Die kommende Bundesregierung müsse schnell nach Amtsantritt „die schweren Strickfehler der vom Bundestag ohne valide Kenntnis der Folgen verabschiedeten Krankenhausreform korrigieren“ und die Krankenhäuser stabilisieren. Dies forderte Ingo Morell, Präsident... [weiter lesen] -
PPP-Richtlinie: Stichprobenprüfung löst Vollerhebung ab
 Berlin – Ab Januar 2025 treten neue Regeln für die Qualitätskontrollen des Medizinischen Dienstes (MD) in Krankenhäusern in Kraft. Sie zielen auf eine effizientere und transparentere Qualitätskontrolle in psychiatrischen und psychosomatischen Kliniken ab und sollen die... [weiter lesen]
Berlin – Ab Januar 2025 treten neue Regeln für die Qualitätskontrollen des Medizinischen Dienstes (MD) in Krankenhäusern in Kraft. Sie zielen auf eine effizientere und transparentere Qualitätskontrolle in psychiatrischen und psychosomatischen Kliniken ab und sollen die... [weiter lesen] -
Junk Food: Mediziner fordern Werbebeschränkungen nach britischem Vorbild
 Berlin – Um Kinder und Jugendliche vor ungesunden Lebensmitteln zu schützen, will Großbritannien Fernseh- und Internetwerbung für bestimmte Lebensmittel künftig stark einschränken. Die britische Regierung hat eine Liste der Lebensmittel mit hohem Fett-, Salz- und... [weiter lesen]
Berlin – Um Kinder und Jugendliche vor ungesunden Lebensmitteln zu schützen, will Großbritannien Fernseh- und Internetwerbung für bestimmte Lebensmittel künftig stark einschränken. Die britische Regierung hat eine Liste der Lebensmittel mit hohem Fett-, Salz- und... [weiter lesen] -
Neue EBM-Leistungen für Long-COVID-Behandlung
 Berlin – Für die Versorgung von Patienten mit Long COVID oder einem Verdacht auf Long COVID werden zum 1. Januar mehrere neue Leistungen in den einheitlichen Bewertungsmaßstab (EBM) aufgenommen. Darauf haben sich die Kassenärztliche Bundesvereinigung (KBV) und der... [weiter lesen]
Berlin – Für die Versorgung von Patienten mit Long COVID oder einem Verdacht auf Long COVID werden zum 1. Januar mehrere neue Leistungen in den einheitlichen Bewertungsmaßstab (EBM) aufgenommen. Darauf haben sich die Kassenärztliche Bundesvereinigung (KBV) und der... [weiter lesen] -
Warnstreik in Niedersachsen: Ärzte kommunaler Kliniken bleiben zu Hause
 Hannover – An rund 40 kommunalen Krankenhäusern in Niedersachsen wollen Ärztinnen und Ärzte heute in den Ausstand treten. Der ganztägige Warnstreik ist als sogenannter stiller Streik geplant: Die Mediziner sollen einfach zu Hause bleiben, wie die Ärztegewerkschaft... [weiter lesen]
Hannover – An rund 40 kommunalen Krankenhäusern in Niedersachsen wollen Ärztinnen und Ärzte heute in den Ausstand treten. Der ganztägige Warnstreik ist als sogenannter stiller Streik geplant: Die Mediziner sollen einfach zu Hause bleiben, wie die Ärztegewerkschaft... [weiter lesen] -
Störung bei Primärsystemanbieter CompuGroup Medical
 Berlin – Eine offenbar flächendeckende Störung liegt aktuell beim Primärsystemanbieter CompuGroup Medical Deutschland AG (CGM) vor. Wie die für die Telematikinfrastruktur (TI) zuständige Gematik mitteilte, kann es dadurch zu Problemen und Einschränkungen beim Einlesen von... [weiter lesen]
Berlin – Eine offenbar flächendeckende Störung liegt aktuell beim Primärsystemanbieter CompuGroup Medical Deutschland AG (CGM) vor. Wie die für die Telematikinfrastruktur (TI) zuständige Gematik mitteilte, kann es dadurch zu Problemen und Einschränkungen beim Einlesen von... [weiter lesen] -
Entscheidung zu Lipidsenkern kommende Woche erwartet
 Berlin – Kommende Woche Donnerstag könnte der Gemeinsame Bundesausschuss (G-BA) über eine Indikationserweiterung von Lipidsenkern entscheiden. Das geht aus einer aktualisierten Tagesordnung des Gremiums für die 12. Sitzung der laufenden Amtsperiode hervor. Möglicherweise... [weiter lesen]
Berlin – Kommende Woche Donnerstag könnte der Gemeinsame Bundesausschuss (G-BA) über eine Indikationserweiterung von Lipidsenkern entscheiden. Das geht aus einer aktualisierten Tagesordnung des Gremiums für die 12. Sitzung der laufenden Amtsperiode hervor. Möglicherweise... [weiter lesen] -
Weniger Atemwegsinfektionen während der Coronapandemie
 Berlin – In den Coronajahren 2020 und 2021 gab es deutlich weniger Atemwegsinfektionen als üblich. Mit dem Abklingen der COVID-19-Pandemie seit 2022 nahmen Versicherte der Krankenkassen wieder deutlich mehr vertragsärztliche Leistungen wegen akuter Atemwegsinfekte in... [weiter lesen]
Berlin – In den Coronajahren 2020 und 2021 gab es deutlich weniger Atemwegsinfektionen als üblich. Mit dem Abklingen der COVID-19-Pandemie seit 2022 nahmen Versicherte der Krankenkassen wieder deutlich mehr vertragsärztliche Leistungen wegen akuter Atemwegsinfekte in... [weiter lesen] -
Arzneimittelausgaben steigen um knapp zehn Prozent
 Frankfurt – Die Arzneimittelausgaben der gesetzlichen Krankenversicherung (GKV) lagen in den ersten drei Quartalen 2024 bei 42,4 Milliarden Euro. Das sind 9,7 Prozent mehr als im Vorjahr. Das geht aus einer Analyse des Marktforschungs- und Beratungsunternehmens IQVia... [weiter lesen]
Frankfurt – Die Arzneimittelausgaben der gesetzlichen Krankenversicherung (GKV) lagen in den ersten drei Quartalen 2024 bei 42,4 Milliarden Euro. Das sind 9,7 Prozent mehr als im Vorjahr. Das geht aus einer Analyse des Marktforschungs- und Beratungsunternehmens IQVia... [weiter lesen] -
Zufriedenheit mit dem Gesundheitssystem hat abgenommen
 Berlin – Die Zufriedenheit mit dem Gesundheitssystem in Deutschland fällt gemischt aus: 45 Prozent der gesetzlich Krankenversicherten sind „sehr zufrieden“ oder „zufrieden“. Damit zeigt sich im Vergleich zu den Vorjahren ein Abwärtstrend. Das geht aus einer... [weiter lesen]
Berlin – Die Zufriedenheit mit dem Gesundheitssystem in Deutschland fällt gemischt aus: 45 Prozent der gesetzlich Krankenversicherten sind „sehr zufrieden“ oder „zufrieden“. Damit zeigt sich im Vergleich zu den Vorjahren ein Abwärtstrend. Das geht aus einer... [weiter lesen] -
Psychotherapie mit Psilocybin half Ärzten in der Pandemie gegen Depressionen
 Seattle – Eine durch die Verabreichung von Psilocybin unterstützte Psychotherapie konnte bei Ärzten und anderen medizinischen Fachkräften, die während der COVID-19-Pandemie an vorderster Front Patienten versorgten, signifikant Depressionen reduzieren. Das berichten... [weiter lesen]
Seattle – Eine durch die Verabreichung von Psilocybin unterstützte Psychotherapie konnte bei Ärzten und anderen medizinischen Fachkräften, die während der COVID-19-Pandemie an vorderster Front Patienten versorgten, signifikant Depressionen reduzieren. Das berichten... [weiter lesen] -
Mpox: Studie zu Tecovirimat wegen mangelnder Wirkung gestoppt
 Bethesda/Maryland – Das Virustatikum Tecovirimat, das für den Fall eines bioterroristischen Angriffs mit Pockenerregern entwickelt wurde, hat in einer internationalen Studie die Erwartung in der Behandlung von Patienten mit Mpox nicht erfüllt. Das US-National Institute of... [weiter lesen]
Bethesda/Maryland – Das Virustatikum Tecovirimat, das für den Fall eines bioterroristischen Angriffs mit Pockenerregern entwickelt wurde, hat in einer internationalen Studie die Erwartung in der Behandlung von Patienten mit Mpox nicht erfüllt. Das US-National Institute of... [weiter lesen] -
Blinatumomab verbessert Ergebnisse der Chemotherapie bei B-Zell-ALL im Kindesalter
Seattle – Der BITE-Antikörper Blinatumomab, der jüngst in einer randomisierten Studie die Behandlungsergebnisse von Erwachsenen mit einer akuten B-Zell-Leukämie verbessert hat, kann auch bei pädiatrischen Patienten das krankheitsfreie Überleben verlängern. Dies zeigen die... [weiter lesen]
Seattle – Der BITE-Antikörper Blinatumomab, der jüngst in einer randomisierten Studie die Behandlungsergebnisse von Erwachsenen mit einer akuten B-Zell-Leukämie verbessert hat, kann auch bei pädiatrischen Patienten das krankheitsfreie Überleben verlängern. Dies zeigen die... [weiter lesen] -
Ständige Impfkommission rät zum Statuscheck von Polio-Impfung
 Berlin – In den vergangenen Wochen sind an mehreren Standorten in Deutschland schluckimpfstoffabgeleitete Polioviren des Typs 2 in Abwasserproben nachgewiesen worden. Die Ständige Impfkommission (STIKO) beim Robert-Koch-Institut (RKI) mahnt nun an, den Impfstatus zu... [weiter lesen]
Berlin – In den vergangenen Wochen sind an mehreren Standorten in Deutschland schluckimpfstoffabgeleitete Polioviren des Typs 2 in Abwasserproben nachgewiesen worden. Die Ständige Impfkommission (STIKO) beim Robert-Koch-Institut (RKI) mahnt nun an, den Impfstatus zu... [weiter lesen] -
Beschwerde gegen Tabaksteuer für E-Zigaretten erfolglos
 Karlsruhe – Eine Verfassungsbeschwerde gegen die Tabaksteuer auf sogenannte Liquids für E-Zigaretten ist am Bundesverfassungsgericht (BVerfG) ohne Erfolg geblieben. Der Erste Senat nahm die Beschwerde von betroffenen Konsumenten und Herstellern nicht zur Entscheidung an,... [weiter lesen]
Karlsruhe – Eine Verfassungsbeschwerde gegen die Tabaksteuer auf sogenannte Liquids für E-Zigaretten ist am Bundesverfassungsgericht (BVerfG) ohne Erfolg geblieben. Der Erste Senat nahm die Beschwerde von betroffenen Konsumenten und Herstellern nicht zur Entscheidung an,... [weiter lesen] -
Illegale Drogen: Kokainkonsum steigt vor allem bei Männern
 Berlin – Einen steigenden Konsum von Kokain sowie anderen Stimulanzien zeigt der heute veröffentlichte REITOX-Jahresbericht der Deutschen Beobachtungsstelle für Drogen und Drogensucht (DBDD) zur Situation illegaler Drogen in Deutschland. Innerhalb von sechs Jahren ist... [weiter lesen]
Berlin – Einen steigenden Konsum von Kokain sowie anderen Stimulanzien zeigt der heute veröffentlichte REITOX-Jahresbericht der Deutschen Beobachtungsstelle für Drogen und Drogensucht (DBDD) zur Situation illegaler Drogen in Deutschland. Innerhalb von sechs Jahren ist... [weiter lesen] -
Gematik: Bekanntheit der ePA für alle steigt an
 Berlin – Eine neue Umfrage der Gematik zeigt einen signifikanten Anstieg der Bekanntheit der elektronischen Patientenakte (ePA) in der deutschen Bevölkerung. Demnach ist innerhalb eines Jahres der Anteil der Bürgerinnen und Bürger, die von der ePA gehört haben, um knapp 20... [weiter lesen]
Berlin – Eine neue Umfrage der Gematik zeigt einen signifikanten Anstieg der Bekanntheit der elektronischen Patientenakte (ePA) in der deutschen Bevölkerung. Demnach ist innerhalb eines Jahres der Anteil der Bürgerinnen und Bürger, die von der ePA gehört haben, um knapp 20... [weiter lesen] -
Verbände für baldige Abstimmung über Liberalisierung des Abtreibungsrechts
 Berlin – Zahlreiche Verbände wie der Deutsche Frauenrat (DF) und der Deutsche Gewerkschaftsbund (DGB) setzen sich für eine baldige Bundestagsabstimmung über die Liberalisierung des Abtreibungsrechts ein. „Kurz vor Ende der Legislatur steht ein langwährender... [weiter lesen]
Berlin – Zahlreiche Verbände wie der Deutsche Frauenrat (DF) und der Deutsche Gewerkschaftsbund (DGB) setzen sich für eine baldige Bundestagsabstimmung über die Liberalisierung des Abtreibungsrechts ein. „Kurz vor Ende der Legislatur steht ein langwährender... [weiter lesen] -
Forscher wollen Entfernung von Nasen-Tumoren mit KI verbessern
 Würzburg – Ein Forscherteam aus Medizinern und Informatikern will die Entfernung von Tumoren in der Nasenhöhle und den Nasennebenhöhlen verbessern. Wie die Universität Würzburg mitteilte, arbeiten die Wissenschaftler aus Würzburg und Flensburg dafür an einem neuen... [weiter lesen]
Würzburg – Ein Forscherteam aus Medizinern und Informatikern will die Entfernung von Tumoren in der Nasenhöhle und den Nasennebenhöhlen verbessern. Wie die Universität Würzburg mitteilte, arbeiten die Wissenschaftler aus Würzburg und Flensburg dafür an einem neuen... [weiter lesen] -
Hüft-Impingement: Operation hat langfristig möglicherweise Vorteile
 Oxford – Beim femoroacetabulären Impingement-Syndrom (FAIS) macht es hinsichtlich der Arthroseprogression wahrscheinlich keinen Unterschied, ob Patienten chirurgisch oder physiotherapeutisch behandelt werden. Aber nach der Operation haben sie langfristig möglicherweise... [weiter lesen]
Oxford – Beim femoroacetabulären Impingement-Syndrom (FAIS) macht es hinsichtlich der Arthroseprogression wahrscheinlich keinen Unterschied, ob Patienten chirurgisch oder physiotherapeutisch behandelt werden. Aber nach der Operation haben sie langfristig möglicherweise... [weiter lesen] -
Pflegekräften droht Abschiebung: Lauterbach verspricht Hilfe
 Berlin/Wilstedt – Bundesgesundheitsminister Karl Lauterbach kündigt an, sich für die von Abschiebung bedrohten Pflegekräfte eines niedersächsischen Pflegeheims einzusetzen. „Ausländische Pflegekräfte sind bei uns mehr als willkommen, weil wir auf sie angewiesen sind und... [weiter lesen]
Berlin/Wilstedt – Bundesgesundheitsminister Karl Lauterbach kündigt an, sich für die von Abschiebung bedrohten Pflegekräfte eines niedersächsischen Pflegeheims einzusetzen. „Ausländische Pflegekräfte sind bei uns mehr als willkommen, weil wir auf sie angewiesen sind und... [weiter lesen] -
Lauterbach: Älteren Menschen die Angst vor Pflegekosten nehmen
 Augsburg – Bundesgesundheitsminister Karl Lauterbach hat eine Struktur- und Finanzreform im Pflegebereich in der nächsten Legislaturperiode gefordert. Auch dürfe „kein älterer Mensch Angst haben, sich Pflege nicht leisten zu können“, sagte der SPD-Politiker der Augsburger... [weiter lesen]
Augsburg – Bundesgesundheitsminister Karl Lauterbach hat eine Struktur- und Finanzreform im Pflegebereich in der nächsten Legislaturperiode gefordert. Auch dürfe „kein älterer Mensch Angst haben, sich Pflege nicht leisten zu können“, sagte der SPD-Politiker der Augsburger... [weiter lesen] -
Chronisch-traumatische Enzephalopathie: Risiko steigt bei Football, Rugby und Eishockey mit jeder Saison
 Boston – Die repetitiven Schädelprellungen, denen Sportler bei sogenannten Vollkontaktsportarten ausgesetzt sind, hinterlassen Spuren im Gehirn. Nachdem frühere Studien bereits auf ein „dosisabhängiges“ Risiko einer chronisch-traumatischen Enzephalopathie (CTE) beim... [weiter lesen]
Boston – Die repetitiven Schädelprellungen, denen Sportler bei sogenannten Vollkontaktsportarten ausgesetzt sind, hinterlassen Spuren im Gehirn. Nachdem frühere Studien bereits auf ein „dosisabhängiges“ Risiko einer chronisch-traumatischen Enzephalopathie (CTE) beim... [weiter lesen] -
Mehrheit für gestaffelten Mutterschutz nach Fehlgeburt
 Berlin – Wer sein Kind vor der Geburt durch eine Fehlgeburt verliert, soll ein Recht auf Mutterschutz haben. Dieser Meinung ist die Mehrheit der Bevölkerung, wie aus einer heute in Berlin veröffentlichten Forsa-Umfrage im Auftrag der mkk – meine krankenkasse hervorgeht.... [weiter lesen]
Berlin – Wer sein Kind vor der Geburt durch eine Fehlgeburt verliert, soll ein Recht auf Mutterschutz haben. Dieser Meinung ist die Mehrheit der Bevölkerung, wie aus einer heute in Berlin veröffentlichten Forsa-Umfrage im Auftrag der mkk – meine krankenkasse hervorgeht.... [weiter lesen] -
Schott Pharma profitiert von Abnehmspritze und Krebstherapie
 Mainz – Der Pharmazulieferer Schott Pharma profitiert vom wachsenden Markt für Abnehmspritzen und neuen Krebstherapien. „Wir versuchen, Pharmatrends zu verstehen“, sagte Unternehmenschef Andreas Reisse in Mainz. „Und dann übersetzen wir das in unser Geschäft für eine... [weiter lesen]
Mainz – Der Pharmazulieferer Schott Pharma profitiert vom wachsenden Markt für Abnehmspritzen und neuen Krebstherapien. „Wir versuchen, Pharmatrends zu verstehen“, sagte Unternehmenschef Andreas Reisse in Mainz. „Und dann übersetzen wir das in unser Geschäft für eine... [weiter lesen] -
Verkehrslärm ist eine Ursache für Leseschwäche
 Brüssel – Mehr als eine halbe Million Schulkinder in Europa haben eingeschränkte Lesefähigkeiten, weil sie permanent Verkehrslärm ausgesetzt sind. Das geht aus einer Datenauswertung der Europäischen Umweltagentur (EEA) hervor, die heute in Kopenhagen veröffentlicht wurde.... [weiter lesen]
Brüssel – Mehr als eine halbe Million Schulkinder in Europa haben eingeschränkte Lesefähigkeiten, weil sie permanent Verkehrslärm ausgesetzt sind. Das geht aus einer Datenauswertung der Europäischen Umweltagentur (EEA) hervor, die heute in Kopenhagen veröffentlicht wurde.... [weiter lesen] -
Fachärzte: Adipositas-Behandelte öfter ungeplant schwanger
 Berlin – Die verstärkt zur Behandlung von starkem Übergewicht eingesetzten Diabetesmedikamente, sogenannte GLP-1-Analoga wie Ozempic, können bei Frauen ersten Untersuchungen zufolge die Wahrscheinlichkeit einer ungeplanten Schwangerschaft erhöhen. Die Deutsche Diabetes... [weiter lesen]
Berlin – Die verstärkt zur Behandlung von starkem Übergewicht eingesetzten Diabetesmedikamente, sogenannte GLP-1-Analoga wie Ozempic, können bei Frauen ersten Untersuchungen zufolge die Wahrscheinlichkeit einer ungeplanten Schwangerschaft erhöhen. Die Deutsche Diabetes... [weiter lesen] -
Synthetische T-Zellen könnten Hirntumore beseitigen, eine Multiple Sklerose lindern und Beta-Zellen im Pankreas schützen
 San Francisco – US-Forschende haben die CAR-T-Zelltherapie weiterentwickelt. Ihre in Science (2024; DOI: 10.1126/science.adl4237 und DOI: 10.1126/science.adl4793) vorgestellten synthetischen synNotch-Zellen haben bei Mäusen das Wachstum von Glioblastomen und... [weiter lesen]
San Francisco – US-Forschende haben die CAR-T-Zelltherapie weiterentwickelt. Ihre in Science (2024; DOI: 10.1126/science.adl4237 und DOI: 10.1126/science.adl4793) vorgestellten synthetischen synNotch-Zellen haben bei Mäusen das Wachstum von Glioblastomen und... [weiter lesen] -
Rotaviren: Lebendimpfstoff auf Intensivstationen sicher
 Philadelphia – Viele neonatale Intensivstationen verzichten auf eine Impfung ihrer jungen Patienten gegen Rotaviren, da sie eine unkontrollierte Ausbreitung von Impfstoffviren auf der Station befürchten. Das Risiko ist nach den Erfahrungen einer US-Klinik in Pediatrics... [weiter lesen]
Philadelphia – Viele neonatale Intensivstationen verzichten auf eine Impfung ihrer jungen Patienten gegen Rotaviren, da sie eine unkontrollierte Ausbreitung von Impfstoffviren auf der Station befürchten. Das Risiko ist nach den Erfahrungen einer US-Klinik in Pediatrics... [weiter lesen] -
Kutaner Lupus erythematodes erhöht Herz-Kreislauf-Risiko
 Dallas/Texas – Ein Lupus erythematodes geht vermutlich auch dann mit einem erhöhten Risiko auf atherosklerotische Herz-Kreislauf-Erkrankungen einher, wenn die Läsionen auf die Haut beschränkt sind. Dies zeigt eine Auswertung von Versichertendaten in JAMA Dermatology (2024;... [weiter lesen]
Dallas/Texas – Ein Lupus erythematodes geht vermutlich auch dann mit einem erhöhten Risiko auf atherosklerotische Herz-Kreislauf-Erkrankungen einher, wenn die Läsionen auf die Haut beschränkt sind. Dies zeigt eine Auswertung von Versichertendaten in JAMA Dermatology (2024;... [weiter lesen] -
Haarverlust: Experten beurteilen orale Low-Dose-Therapie mit Minoxidil
 San Francisco – Die topische Behandlung mit Minoxidil führt bei Patienten mit androgenetischer Alopezie und anderen Formen des Haarverlusts nicht immer zu den erhofften Ergebnissen. In einer Delphi-Befragung haben sich Experten aus 12 Ländern über den Einsatz von oralen... [weiter lesen]
San Francisco – Die topische Behandlung mit Minoxidil führt bei Patienten mit androgenetischer Alopezie und anderen Formen des Haarverlusts nicht immer zu den erhofften Ergebnissen. In einer Delphi-Befragung haben sich Experten aus 12 Ländern über den Einsatz von oralen... [weiter lesen] -
Ärzte sehen großen Weiterbildungsbedarf bei Künstlicher Intelligenz
 Berlin – Die Mehrheit der Ärzte in Deutschland hält Künstliche Intelligenz (KI) in der Medizin künftig für unverzichtbar, sieht aber einen großen ungedeckten Informationsbedarf. Kassenärztliche Vereinigungen wie jene in Berlin (KV Berlin) wollen dem mit neuen... [weiter lesen]
Berlin – Die Mehrheit der Ärzte in Deutschland hält Künstliche Intelligenz (KI) in der Medizin künftig für unverzichtbar, sieht aber einen großen ungedeckten Informationsbedarf. Kassenärztliche Vereinigungen wie jene in Berlin (KV Berlin) wollen dem mit neuen... [weiter lesen]
Follow @Artze_News on Twitter!

